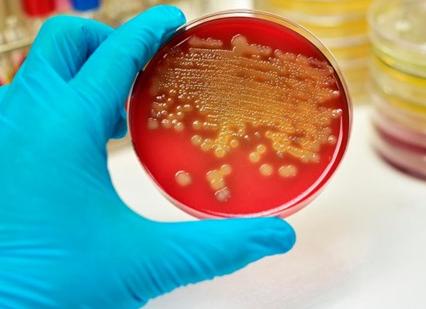
Анализ кала скрытая кровь что это значит

Что делать, если анализ кала на скрытую кровь оказался положительный? Что это значит и как лечить?
Анализ на скрытую кровь — это возможность выявить заболевания, которые нельзя заметить при сдаче простых анализов. Исследование позволяет выявить разнообразные серьезные заболевания, которые характеризуются повреждениями пищевого тракта. В том числе и различные раковые опухоли, болезнь Крона, язвенный колит и прочие.
Причины
Анализ на скрытую кровь назначается лечащим врачом в случае подозрения на кровотечения в органах ЖКТ. Данная проблема может стать признаком многих заболеваний, в том числе и онкологических.
Онкологические проблемы с толстым кишечником уже на начальном этапе проявления могут вызывать постоянные несильные кровотечения. Они появляются вследствие того, что новообразования, состоящие из раковых клеток часто кровоточат и кровь напрямую попадает в толстый кишечник.
В этом случае кровь в кале можно выявить при помощи обычного анализа. Но в редких случаях кровь получается обнаружить только при проведении анализа на скрытую кровь.
Положительный результат анализов может быть вызван следующими заболеваниями:
- гельминтоз (заражение крупными гельминтами, которые могут травмировать стенки кишечника);
- полипоз (разрастание полипов в кишечнике);
- язва (воспаленная микротравма кишечника, вызванная бактериями);
- воспалительные процессы на слизистой желудка и в кишечнике;
- геморрой и геморрагический диатез;
- брюшной тиф;
- патологии желудка;
- болезнь Крона;
- новообразования в толстом кишечнике;
- патология двенадцатиперстной кишки;
- раковые опухоли.
Расшифровка
Скрытая кровь может быть обнаружена только при помощи микроскопического анализа или анализа на гемоглобин (гваяковой пробы). Допускается использование тестов на основе моноклональных антител, реагирующих на присутствие гемоглобина.
Высокая чувствительность таких тестов позволяет считать их значительно лучше обычных экспресс-методов.
Стоит учитывать, что в некоторых случаях положительная реакция может быть и у полностью здорового человека, поэтому точно определить нарушение могут только специалисты.
В норме, реакция на скрытую кровь должна быть отрицательной.
Если реакция положительная, есть подозрение на хронические патологии, связанные с ЖКТ. Обычно это повреждения слизистой оболочки.
В этом случае кровь может проникать в просвет толстой или тонкой кишки, желудок. При этом обнаружить такое нарушение можно только при помощи анализа на скрытую кровь.
Также причинами положительной реакции могут стать:
- колиты;
- язва двенадцатиперстной кишки;
- неспецифический язвенный колит.
Но ложный положительный результат проявляется в том случае, если кровь попала в желудок из полости рта, когда человек страдает геморроидальными кровотечениями, гематурией, глистной инвазией и прочими. Также причины могут быть в сильных напряжениях при дефекации и при неаккуратной сдаче кала на анализ при месячных.
Что делать, если анализ положительный?
В том случае, если анализ положительный, необходимо пройти диагностику. Первоначально это должна быть колоноскопия. Такая диагностика позволяет увидеть точное расположение просветов в нижнем отделе кишечника.
При необходимости можно провести биопсию, после которой будет получена более точная информация о причине возникновения скрытой крови в кале.
Если причиной появления данной патологии стало развитие опухоли, в дальнейшем придется провести консультацию у онколога, а также провести магнитно-резонансную томографию.
Лечение
Лечение после выявления положительного результата анализа, необходимо обсуждать только с врачом.
Ни в коем случае нельзя самостоятельно прописывать себе лекарства или пользоваться приемами народной медицины, поскольку они могут причинить организму еще больший вред.
Положительный анализ у грудничка и детей до трех лет
Любое изменение концентрации и цвета стула у грудничка вызывает у родителей беспокойство. Но при одинарном изменении стула беспокоиться не стоит. Но если алая примесь в кале проявляется регулярно, необходимо пройти консультацию у врача и сдать анализ на скрытую кровь в кале.
Довольно частой причиной появления крови в кале является непереносимость малышом коровьего молока. Проблемы могут возникнуть даже в том случае, если молоко употребляет мать ребенка, которая продолжает кормление грудью. Проблемы могут начаться и если мать употребляет в пищу сливочное масло, сметану, сыры и прочие молочные продукты.
В случае если ребенок находится на искусственном вскармливании, необходимо тщательно подбирать смесь без содержания белка коровьего молока.
Если у грудничка анализ на скрытую кровь в кале положительный, проблема может быть в воспалительных заболеваниях кишечника:
- дисбактериоз;
- амебиаз;
- колит;
- дизентерия;
- балантидиаза.
Точный диагноз устанавливается только на основе обследования и копрограммы.
Еще одной причиной возникновения скрытой крови в кале может стать инфекция, вызванная введением в пищу малыша взрослых продуктов.
Такая проблема может также сопровождаться рвотой, поносами, болями в животике, высокой температурой.
У детей постарше (от двух лет), положительная реакция на скрытую кровь в кале может наблюдаться в случае возникновения проблем в толстом кишечнике — ювенильных полипов. Такие образования не причиняют ребенку дискомфорта и не опасны для его здоровья. При желании или необходимости их можно удалить.
загрузка…
Копрограмма на скрытую кровь
Кал – это конечный результат деятельности желудочно-кишечного тракта человека, который формируется в толстом кишечнике в результате множества химических и биологических процессов. Анализ кала – копрограмма — позволяет диагностировать множество заболеваний ЖКТ и внутренних органов человека. В некоторых случаях именно копрограмма позволяет поставить верный диагноз и догадаться о внутреннем заболевании, которое имеет слабые симптомы.
Анализ кала – копрограмма — позволяет диагностировать множество заболеваний ЖКТ и внутренних органов человека
Что такое копрограмма кала?
Расшифровка копрограммы базируется на таких показателях:
- химические и физические свойства кала;
- исследование материала под микроскопом;
- исследование на предмет наличия патогенной микрофлоры;
- определение в кале скрытой крови;
- выявление яиц паразитов.
Достоверность результатов общего анализа кала зависит от режима питания за 2-3 дня. Нельзя употреблять копчености, алкоголь, кофе, чай, продукты, раздражающие кишечник и желудок, а также делать большие перерывы между приемами пищи (оптимально питаться 5 раз в день небольшими порциями). По возможности нужно воздержаться от приема лекарственных препаратов и исключить медикаменты, содержащие железо, так как это может вызывать ложноположительный результат на скрытую кровь. Перед сдачей кала на копрограмму нельзя употреблять препараты, влияющие на работу кишечника (противодиарейные или слабительные), а также использовать ректальные свечи.
Важно, чтобы кал был доставлен в лабораторию в течение 8 часов, а если нужен бактериологический анализ или обследование на наличие яиц остриц, то материал должен быть максимально свежим.
Расшифровка копрограммы у детей и взрослых
После проведения анализа пациент получает таблицу, в которой показаны результаты исследования. Расшифровкой анализа кала занимается обычно лечащий врач, но нелишним будет знать основные показатели. Чтобы понять, все ли в порядке, достаточно отыскать показатели нормы в интернете или энциклопедии и сравнить в режиме онлайн с полученными данными.
Количество и консистенция кала
Несмотря на то, что для анализа достаточно 10-15 г материала, первое, на что нужно обратить внимание помимо результатов анализа – это количество кала. В норме для взрослого человека его количество составляет от 150 до 600 г в сутки, для ребенка – 80- 150 г, многое зависит от питания и питьевого режима. Слишком обильный стул может свидетельствовать о таких заболеваниях:
- неспецифический язвенный колит;
- болезнь Крона;
- энтерит;
- панкреатит;
- рак толстой кишки;
- механическая желтуха.
Скудный стул может говорить о язвенной болезни, хроническом колите, микседеме.
Что касается консистенции, то она должна быть средней плотности. Слишком жидкий стул может вызываться кишечными заболеваниями, нарушением питания, отравлением, дисбактериозом и даже стрессом. Слишком плотные, твердые фекалии возникают из-за слишком сильного всасывания жидкости в кишечнике, недостаточного питья, частых запоров.
В норме кал имеет коричневый цвет, который образуется стеркобилином. Это результат распада билирубина, он попадает в кишечник через двенадцатиперстную кишку вместе с желчью. Изменение цвета может быть обусловлено различными причинами, а именно:
- Желтый, светлый. Наблюдается при частом употреблении молочных продуктов.
- Желтый, яркий. Это верный признак диареи, вызванной инфекцией или несварением, также наблюдается при приеме препаратов, содержащих сенну.
- Темно-коричневый. Может говорить о чрезмерном употреблении мяса, разрушении камней в желчном пузыре или гемолитической желтухе.
- Черный (мелена). Может вызываться особенностями питания (большое количество черной смородины, печени животных, кровяной колбасы и пр.). Если таких особенностей нет, то мелена может быть признаком кровоточащей язвы желудка или двенадцатиперстной кишки, кровотечении из увеличенных вен пищевода, так как кровь, смешиваясь с желудочным соком, дает черный цвет. Также возможна закупорка вен селезенки и цирроз печени.
- Зеленоватый. Может быть связано с диетой, включающей в себя множество зелени, богатой клетчаткой. Также может свидетельствовать о заболеваниях печени и недостаточном выделении желчи.
- Красноватый. Также может быть связан с диетой (употребление большого количества томатов) или с кровотечениями в нижней части кишечника, а именно в ободочной и прямой кишке.
- Обесцвеченный. Такой стул бывает у людей с нарушенным поступлением в кишечник стеркобилина. Это бывает при желчекаменной болезни, желтухе, циррозе печени, спайках желчного протока, раке поджелудочной железы и Фаерова сосочка 12-перстной кишки.
- Стул, напоминающий рисовый отвар с хлопьями наблюдается при холере.
- «Гороховый суп» — верный признак тифа.
В норме кал имеет специфический, но не резкий запах, который может усиливаться или ослабевать в зависимости от питания. При большом количестве мясных продуктов в рационе и диарее запах может усиливаться, а при растительном питании и запорах ослабевает.
Очень резкий, неприятный запах является свидетельством гнилостных процессов в кишечнике или пищевого отравления. Повышенное содержание жирных кислот в стуле выражается в резком кисловатом запахе.
Скудный стул может говорить о язвенной болезни, хроническом колите или микседеме
Примеси, видные невооруженным глазом
Как правило, в кале не содержится никаких примесей, он относительно однородный. В нем не должно быть ни каловых камней, ни крови, ни слизи, ни гельминтов или кусков непереваренной еды.
Комки пищи могут свидетельствовать о диарее, атрофическом гастрите или нарушенной работе поджелудочной железы. Непереваренная кожура фруктов, семена, орехи, мелкие косточки считаются нормой.
Большое количество слизи говорит о воспалительных процессах кишечника, а также неинфекционных (язвенный колит) и инфекционных (сальмонеллез, дизентерия) заболеваниях.
Наличие жира в кале говорит о болезнях поджелудочной железы. В фекалиях при этом могут наблюдаться белые комочки.
Если невооруженным глазом видна кровь, значит присутствует кровотечение в нижних отделах кишечника. Если наблюдается ускоренная моторика (диарея), то кровотечение может быть и в верхних отделах.
Гной в кале встречается крайне редко, как правило, он наблюдается при тяжелых воспалительных процессах и нагноениях.
Камни бывают результатом заторможенной работы кишечника (каловые камни) или слабого оттока желчи (желчные камни).
Скрытая кровь и белок
При проведении реакции на скрытую кровь ее наличие может объясняться присутствием в рационе полусырого мяса, кровяной колбасы, кровоточивости десен, прием препаратов, содержащих железо. Если эти моменты исключаются, то наличие скрытой крови говорит о том, что возможны:
- Кровоточащие язвы желудка и двенадцатиперстной кишки;
- Болезни десен и полости рта, вызывающие потерю крови;
- Полипы кишечника;
- Варикозное расширение вен прямой кишки и пищевода;
- Носовые кровотечения;
- Колиты;
- Дизентерия;
- Брюшной тиф;
- Геморрой;
- Заражение глистами;
- Кровоточащие новообразования.
В норме белок в фекалиях должен отсутствовать, но он может быть обнаружен при хронических воспалениях желудочно-кишечного тракта, целиакии и дисбактериозе.
Анализ на стеркобилин и билирубин
Билирубин в чистом виде не встречается в стуле здорового человека, только продукт его распада — стеркобилин. Исключение составляют дети до года, питающиеся молоком. У них билирубин при общем анализе кала может быть обнаружен, а испражнения пи этом имеют зеленоватый цвет. У взрослых или детей старшего возраста наличие билирубина свидетельствует о сильной диарее или запущенном дисбактриозе, особенно вызванном приемом антибиотиков.
Если в стуле слишком можно стеркобилина, то у пациента наблюдается гемолиз эритроцитов (бывает при отравлении агрессивными химическими веществами) или гиперфункции селезенки.
Недостаток стеркобилина обуславливается теми же причинами, что и обесцвечивание кала.
Микроскопическое исследование позволяет определить наличие в фекалиях таких примесей:
- соединительные волокна;
- мышечные волокна;
- жир и его производные;
- крахмал;
- растительная клетчатка;
- лейкоциты;
- эпителий кишечника;
- простейшие;
- грибы и бактерии;
- кристаллические образования;
- эритроциты.
Все вышеперечисленные элементы, кроме некоторых бактерий и грибов, должны отсутствовать в анализе здорового человека.
Микроскопическое исследование позволяет определить наличие в фекалиях различных примесей
Важно! После того, как вы самостоятельно расшифруете копрограмму, необходима консультация с врачом, так как лишь на общем анализе кала построить верный диагноз крайне сложно. Лечение и дополнительные обследования также должен назначить врач. Если вы обнаружили патологические изменения в стуле, необходимо проконсультироваться с врачом.
Копрограмма у детей
У новорожденных детей пищеварение имеет свои особенности, о которых необходимо знать родителям. В первую неделю жизни испражнения младенца (меконий) имеют темно-зеленый цвет. По мере заселения кишечника бактериями цвет сменяется желтоватым и коричневым, а структура кала становится неоднородной. У детей, которых кормят смесями, зеленоватый оттенок испражнений пропадает намного быстрее.
В первую неделю жизни испражнения младенца (меконий) имеют темно-зеленый цвет
Стул у грудничка полностью зависит от его питания, и врачу перед назначением копрограммы необходимо знать, питается ребенок молоком матери или находится на искусственном вскармливании.
Нормальное количество кала у грудного ребенка составляет от 35 до 55 грамм, при этом малыши на грудном вскармливании имеют более обильный стул. В нем должны отсутствовать белок, эритроциты, скрытая кровь. В небольшом количестве допустимы лейкоциты, мышечные волокна, капли жира, слизь.
Расшифрованную таблицу копрограммы должен анализировать врач и назначать соответствующее лечение, так как пищеварение ребенка имеет свои отличительные черты. Одни и те же признаки у взрослых и грудничков могут говорить о разных заболеваниях.
Часто нарушения пищеварения наблюдаются у грудных детей летом, когда их мамы употребляют различные овощи и фрукты. От того, что ест мать, напрямую зависит работа ЖКТ ребенка, который питается грудным молоком.
источник: simptom-lechenie.ru
Копрограмма – это диагностическое исследование кала, позволяющее выявить нарушение работы органов пищеварительного тракта, наличие воспалительного процесса и дисбаланса кишечной микрофлоры, присутствие паразитов, а также помогающее оценить результаты проведенного лечения.
При получении кала лаборант проводит его визуальный осмотр. Оцениваются внешние показатели (цвет, запах, консистенция и форма), определяются видимые примеси (слизь, гной, кровь) и инородные объекты. На предмет воспалительных процессов и скрытых кровотечений желудочно-кишечного тракта кал подвергают химическому анализу. Дальнейшее исследование материала проводится под микроскопом врачом клинической лабораторной диагностики. В его задачи входит обнаружение остатков переваренной пищи, кристаллов солей, клеток воспаления (лейкоциты, слизь) и кровотечения (эритроциты), яиц гельминтов и цист простейших.
Показатели кала: пояснения и нормы
- Количество
- Консистенция и форма
- Цвет
- Запах
- Присутствие слизи
- Гнойный экссудат
- Кровь
- Остатки не переваренной пищи
- Паразиты
- Общая реакция кала (рН)
- Реакция Грегерсена на скрытую кровь
- Определение стеркобилина
- Проба на присутствие билирубина
- Реакция Вишнякова-Трибуле на растворимый белок
- Детрит
- Наличие мышечных волокон
- Соединительная ткань
- Нейтральный жир, жирные кислоты и их соли (мыла)
- Перевариваемая клетчатка
- Крахмал
- Лейкоциты
- Эритроциты
- Кристаллические образования
- Слизь
- Йодофильная флора
- Непатогенные простейшие
- Яйца паразитических червей и цисты патогенных простейших
Физические свойства (макроскопия) анализа кала
Количество испражнений за сутки. Зависит от объема съеденной пищи и ее характера. При полноценном питании здоровый человек выделяет за сутки 100-200 г кала. При употреблении больших объемов растительной клетчатки количество испражнений увеличивается до 350-500 г.
Консистенция и форма. В норме кал плотный. Оформлен в виде «колбаски».
Цвет. Во многом зависит от характера употребляемой пищи. При сбалансированном питании кал имеет коричневый цвет с различными оттенками. Употребление больших объемов молочных продуктов снижает интенсивность окраски испражнений. Цвет приближается к желтому. Избыток мясной пищи в рационе усиливает окрашивание каловых масс до темно-коричневого. При употреблении свеклы испражнения приобретают красноватый оттенок. А вот поедание больших объемов зелени (салат, шпинат, укроп, петрушка) изменяет цвет кала до болотного. У любителей кофе и какао испражнения приобретают угольный оттенок. Такой же цвет имеет кал при большом количестве в пище ягод черной смородины.
Некоторые лекарственные препараты способны оказывать влияние на данный признак копрограммы. Прием препаратов железа и висмута изменяет цвет кала в зеленовато-черный. Слабительные с сенной дают испражнениям желто-коричневое окрашивание. Активированный уголь изменяет цвет каловых масс до черного. Сернокислый барий, применяемый в рентгенологической практике, окрашивает испражнения в светло-желтый и белый цвет. Эти знания помогут избежать ложной диагностики заболеваний пищеварительной системы при оценке исследования копрограммы.
Запах. Обусловлен присутствием ароматических продуктов распада (индол, скатол) белковых соединений. В норме каловый нерезкий. При обилии в питании мясной пищи запах усиливается.
Видимые примеси. В норме кал представляет собой однородную массу без посторонних объектов. При плохом пережевывании пищи в испражнениях могут появляться крупные комки не переваренных остатков еды. Также в кале встречаются косточки ягод и фруктов (вишня, виноград, арбуз, абрикос и т. д.), случайно заглатываемые и проходящие транзитом через пищеварительный тракт. Они не перевариваются. У маленьких детей в кале могут обнаруживаться инородные тела (пуговицы, детали мелкого конструктора и т. д.). Другие примеси (слизь, гной, кровь) видны только при патологии органов пищеварения. После проведенной антигельминтной терапии в кале могут обнаруживаться тела и членики паразитических червей (аскарид, остриц и других).
Химическое исследование анализа кала
Общая реакция кала (рН). В норме нейтральная или слабощелочная (7,0 – 7,5). У грудных детей реакция кислая.
Скрытая кровь. Ее можно обнаружить реакцией Грегерсена. Чтобы проба была достоверной, необходимо перед исследованием придерживаться 3-дневной диеты. Для этого исключаются продукты, содержащие много белка (мясо, рыба, колбаса, яйца), а также зеленые овощи. Отменяются препараты железа. Лаборанты проводят бензидиновую пробу на скрытую кровь. В норме она отрицательная.
Стеркобилин. У детей с 7-месячного возраста и взрослых в испражнениях присутствует всегда. Является индикатором окраски кала в коричневый цвет.
Билирубин. В норме отсутствует. В меконии новорожденных и кале грудных детей до 4-месячного возраста билирубин определяется.
Растворимый белок. Выявляется пробой Вишнякова-Трибуле. Белок носит воспалительную природу, включает в себя слизь, экссудат, муцин. В норме в кале не встречается.
Микроскопия анализа кала
Детрит. Это основной фон нормального кала. Представляет собой массу мелких частиц, состоящих из продуктов распада клеток, остатков пищевых веществ и бактерий.
Мышечные волокна. Встречаются в кале в небольшом количестве. При частом употреблении мясной пищи мышечных волокон много.
Соединительная ткань. В норме отсутствует. Но бывают случаи, когда в кале обнаруживаются остатки не переваренной соединительной ткани (кости, хрящи). Это не является патологией.
Нейтральный жир и жирные кислоты. В нормально сформированном кале практически отсутствуют. Остатки жирной пищи в небольшом количестве выделяются с калом преимущественно в виде мыл – щелочных и щелочноземельных солей жирных кислот.
Перевариваемая растительная клетчатка. Представлена неусвояемыми полисахаридами. Клетчатка не дает питательных веществ. Проходя через желудочно-кишечный тракт, она полностью переваривается и формирует кал. В норме в кале отсутствует. Могут определяться единичные не переваренные клетки.
Крахмал. В копрограмме отсутствует. В процессе пищеварения на крахмал воздействуют различные ферменты, начиная с птиалина слюны и заканчивая секретом бактерий толстого кишечника. Это приводит к полному его расщеплению.
Лейкоциты. При микроскопии кала не выявляются, либо присутствуют единичные в поле зрения.
Эритроциты. В норме не встречаются.
Кристаллические образования в кале не определяются. Но есть исключение. Кристаллы оксалата кальция могут встречаться при употреблении в пищу большого количества свежих овощей.
Слизь появляется при воспаление, поэтому в нормальном кале ее нет.
Йодофильная флора. К ней относятся условно-патогенные кишечные бактерии, которые при неблагоприятных обстоятельствах становятся возбудителями опасных инфекций и воспалений. В норме эти микроорганизмы выделяют ферменты для переваривания крахмала и углеводных соединений, участвуют в процессе брожения. Такое название йодофильная флора получила из-за химической реакции. Препарат для микроскопии окрашивают раствором Люголя (йодный раствор) с целью лучшей визуализации бактерий. Они приобретают черный или темно-синий цвет. При микроскопии отсутствуют, либо единичные в препарате. Большое количество йодофильной флоры может наблюдаться у людей, употребляющих в пищу значительные объемы углеводистых и крахмальных продуктов (овощи и фрукты).
Непатогенные простейшие (кишечная и карликовая амебы, споровики и другие) могут присутствовать у здоровых людей.
Паразитические черви и их яйца, патогенные простейшие и их цисты в норме не обнаруживаются. Циста – это форма жизни простейших, имеющая твердую оболочку.
Как правильно сдавать копрограмму?
Подготовка к сдаче анализа
- При имеющихся заболеваниях пищеварительной системы – придерживаться соответствующего диетического стола (по Певзнеру) в течение недели.
- Всем необходимо исключить из питания жирные продукты растительного происхождения (орехи, семечки), а также трудно перевариваемое мясо (баранина) и сырокопченые колбасные изделия. Также запрещаются овощи, ягоды, напитки с красящим эффектом (изменяют цвет каловых масс): свекла, помидоры, черная смородина, кофе и т. д. Эти ограничения нужно соблюдать на протяжении 3-х дней до начала исследования.
- Отменяются медикаментозные средства, изменяющие внешний вид испражнений и активирующие перистальтику кишечника (слабительные средства, сорбенты, препараты железа). Недозволителен прием антибиотиков, так как они нарушают баланс нормальной микрофлоры и усиливают бродильные процессы. Отмену препаратов производят за 7 дней до копрограммы.
- При необходимости выявления скрытых кровотечений желудочно-кишечного тракта проводится 3-5-дневная диета с исключением белковых продуктов (мясо, рыба, яйца и т.д.) и зеленых овощей.
- Накануне исследования отменяются ректальные свечи и диагностические процедуры, оказывающие раздражающее действие на анальное отверстие и прямую кишку (клизмы, ректороманоскопия, колоноскопия).
Выбор тары
Во избежание получения недостоверных результатов копрограммы нужно собирать материал в чистую сухую посуду. Удобнее использовать специальные пластиковые контейнеры с ложкой для анализа кала. Они продаются в аптеках. Также можно собирать кал в небольшую стеклянную банку объемом 100-200 мл из-под детского питания или других продуктов. Перед применением тару тщательно моют теплой водой с моющим средством, затем обдают кипятком и просушивают. Аптечные контейнеры споласкивать водой не нужно, они стерильны.После отбора материала тару плотно закрывают крышкой. При необходимости ставят в холодильник.
Нельзя использовать для сбора кала коробки из-под спичек. Целлюлоза забирает из испражнений влагу, поэтому результаты исследования искажаются.
Правила сбора материала
- Перед актом дефекации необходимо провести гигиенические процедуры – подмыться теплой водой с детским мылом.
- Затем нужно самопроизвольно опорожнить кишечник в чистый сухой горшок или на одноразовую пеленку. Унитаз для этих целей не подойдет: произойдет обсеменение кала различными микроорганизмами и результат исследования будет недостоверным. Неприемлемо попадание в испражнения мочи или воды после клизмы! Женщинам во время менструации, из-за возможного попадания крови, нельзя собирать материал для копрограммы.
- С помощью специальной ложки или деревянного шпателя берем кал сверху из нескольких мест (не менее 3-х). Помещаем его в пластиковый контейнер или чистую стеклянную банку. Объем материала небольшой: достаточно заполнить тару на 1/3. Закрываем плотно крышкой.
- При необходимости ставим в холодильник.
- Доставляем материал в лабораторию вместе с направлением на копрограмму.
Условия хранения кала перед исследованием
Лучше всего приносить материал в лабораторию «свежим» – после утренней дефекации. Но не у всех кишечник работает как часы. Поэтому собрать кал можно с вечера, а доставить его в лабораторию на следующий день: не позднее чем через 8-12 часов после акта дефекации. В течение положенного времени материал хранят в холодильнике при температуре 3-5°С. Нельзя оставлять кал в теплом месте. Это приведет к размножению в нем различных микроорганизмов и активации ферментных процессов, соответственно исказятся результаты копрограммы.
Особенности анализа кала у грудных детей
У малышей до года отследить опорожнение кишечника не сложно. Дефекация у них частая (от 4-10 раз сутки), в редких случаях (при хорошем усвоении грудного молока или склонности к запорам) – 1 раз в 2-3 дня. Так как малыши еще не ходят на горшок, кал собирают прямо с одноразовых подгузников. Жидкий стул ребенка можно слить в стерильный контейнер, кашицеобразный – собрать с помощью специальной ложки. Иногда для удобства родителям рекомендуют использовать одноразовые мочесборники. Они продаются в аптечных киосках. С помощью липучек мочесборник крепится в области анального отверстия грудного ребенка. После того как малыш совершит дефекацию, содержимое переливают в нужную тару. Объем кала для исследования небольшой – примерно чайная ложка.
Если испражнения собраны накануне дня доставки биоматериала, хранить их нужно в холодильнике при температуре 3-5°С. В лабораторию кал доставляют не позднее 12 часов от момента опорожнения кишечника.
Важно также правильно подготовить ребенка к сдаче копрограммы. Если малыш на грудном вскармливании – маме нельзя менять свой рацион блюд. Детям, находящимся на искусственном питании, запрещается вводить другие смеси. Не используются новые прикормы. Привычный режим питания нужно соблюдать в течение недели до начала исследования.
Запрет действует и на лекарственные препараты. За 7 дней до копрограммы ребенку отменяют препараты железа, антибиотики. Накануне исследования не используют слабительные средства и ректальные свечи.
Расшифровка показателей копрограммы: норма и патология
Макроскопия
- Фрагментированная Лентовидная или карандашная
- Форма шаровидных образований («овечий кал»)
- Кашицеобразная
- Жидкая
- Твердая
- Пенистая
- Мазевидная
- Черный (дегтеобразный)
- Темно-коричневый
- Светло-коричневый
- Красноватый
- Желтый
- Светло-желтый
- Серовато-белый
- Гнилостный
- Зловонный
- Слабый
- Нерезкий
- Кислый
- Масляной кислоты
- Незначительное количество (+)
- Значительное количество (++)
Количество кала при дефекации. В норме 100-200 г. Важным компонентом, определяющим объем и вес каловых масс, является вода. При поносах, за счет уменьшения ее всасываемости, суточное количество испражнений значительно увеличивается, а при запорах – уменьшается.
При нарушении усвояемости продуктов питания (сжижение или отсутствие желудочного сока, недостаточность ферментов поджелудочной железы и т. д.) выделяется значительный объем каловых масс (до 1 кг и более), а основная часть пищи выводится не переваренной.
Форма. В норме цилиндрическая. При запорах кал выделяется в виде шаровидных образований – «овечий». При опухолях прямой или сигмовидной кишки форма испражнений лентовидная или карандашная. При спастическом колите –воспалительное заболевание толстой кишки – выделяется фрагментированный кал.
Консистенция. В норме плотная.
- Жидкий стул появляется при неполном расщеплении пищи в тонком кишечнике вследствие гнилостного дисбактериоза или ускоренного выведения каловых масс. Колиты, сопровождающиеся повышенной секрецией желез либо эрозивно-язвенными дефектами слизистой, также характеризуются водянистыми испражнениями.
- Мазевидная или тестообразная консистенция стула наблюдается при поражении поджелудочной железы и закупорке желчных протоков, обусловлена нарушением усвоения жиров.
- Кашицеобразные испражнения характерны для колитов с диареей вследствие бродильного дисбактериоза или ускоренного выведения кишечного содержимого.
- Твердый стул встречается при хронических запорах и закупорке желчных протоков. Пенистый кал – только при нарушении пищеварения по типу бродильной диспепсии.
Цвет. В норме коричневый. Различные патологические состояния влияют на изменение цвета кала:
- при вирусном гепатите или закупорке желчных путей – глинистый (серовато-белый);
- при кровотечениях из желудка – «дегтярный стул» (мелена);
- при гнилостных процессах в кишечнике, запорах, повышенной секреции желез и гастрите с пониженной кислотностью – более темный (темно-коричневый);
- при бродильном дисбактериозе и ускоренном выведении химуса (пищевого комка) – более светлый (светло-коричневый);
- при ферментативной недостаточности поджелудочной железы – светло-желтый;
- при эрозивно-язвенном колите и кровотечениях в нижних отделах пищеварительного тракта – красноватый (алый).
Некоторые опасные инфекции сопровождаются выделением специфических испражнений, помогающих в диагностике заболеваний. При брюшном тифе цвет и вид кала напоминает гороховый суп, при холере – рисовый отвар. При дизентерии в испражнениях присутствуют примеси крови со слизью.
Запах. В норме каловый нерезкий.
- Гнилостный – при одноименной кишечной диспепсии, неполном желудочном переваривании, нарушении кишечной перистальтики и распадающихся опухолях.
- Запах масляной кислоты наблюдается при ускоренном выведении каловых масс.
- Недостаточность ферментов поджелудочной железы, закупорка желчных протоков, а также повышенная секреторная функция толстой кишки сопровождаются выделением зловонного кала.
- Нерезкий запах испражнений – при эрозивно-язвенном колите.
- Кислый кал появляется при кишечном брожении, сопровождающемся дисбалансом микрофлоры и образованием летучих жирных кислот.
- При длительном голодании, запорах, а также ускоренном выведении химуса из нижних отделов пищеварительного тракта выделяется стул со слабыми ароматическими свойствами.
Остатки непереваренной пищи. В норме могут определяться частицы растительной клетчатки. При заболеваниях желчного пузыря и поджелудочной железы в кале обнаруживаются крупные комки не переваренной пищи.
Слизь. В норме нет. Причиной появления слизи является воспалительный процесс в кишечнике. Чаще всего слизь наблюдается при запорах. Так проявляется защитная реакция организма на хроническое раздражение кишечника каловыми массами.
Кровь. В норме нет. При концентрации элементов крови более 6% кал окрашивается в красный цвет. Определяется при эрозиях и полипах сигмовидной кишки, при раковых опухолях в нижних отделах пищеварительного тракта, геморрое, трещине анального отверстия.
Гной. В норме не определяется. Визуально виден в кале при туберкулезном поражении толстого кишечника, при дизентерии, при распадающейся опухоли в нижних отделах пищеварительного тракта.
Паразиты. В норме не видны. При глистных инвазиях в кале обнаруживаются целые особи (аскариды, острицы) или их фрагменты (членики ленточных червей).
источник: prokishechnik.info
При возникновении симптомов до того, как назначать лечение врач должен подтвердить диагноз с помощью объективных исследований. Прежде всего, проводится лабораторные тесты, которые способны показать отклонение от нормы.
Больному назначают общий анализ крови, кала, мочи. Если у специалиста есть подозрение, что развивается патология желудочно-кишечного тракта, приводящая к внутреннему кровотечению, то назначается тест для того чтоб его обнаружить.
Зачем проводят анализ для обнаружения скрытой крови в кале
При патологии слизистой пищевода, желудка, двенадцатиперстной кишки каловые массы становятся почти черным или темно-красными из-за контакта крови с ферментами. Если нарушена целостность кишок, то кал приобретает ярко-красный цвет. При значительных кровотечениях пациент нуждается в экстренной медицинской помощи.
Кровотечение не всегда постоянное, язвы и воспаления кровоточат периодически. При небольшом вовлечении кровеносных сосудов в патологический процесс оттенок каловых масс и их консистенция не изменяется.
Если при копрограмме кровь не обнаружена, а врач подозревает скрытое кровотечение, то пациент должен сдать другой анализ. Реакция на скрытую кровь в кале бывает положительная, при этом необязательно кровотечение присутствует, то есть результат ложноположительный.
Когда сдают тест
Анализ на скрытую кровь рекомендован, если у пациента присутствуют следующие симптомы:
- боль в животе, которая постоянна или возникает периодически;
- тошнота и рвота;
- изжога;
- опорожнения по консистенции отличаются от нормы (кашицеобразные);
- ложные позывы к дефекации;
- частые запоры;
- диарея;
- потеря веса, отсутствие аппетита;
- гипертермия.
Исследование позволяет подтвердить диагноз. Оно также проводится, если у пациента с помощью других диагностических методов были обнаружены заболевания ЖКТ. Результаты помогут специалисту понять степень поражения слизистой и определить тяжесть заболевания, а повторный тест покажет, насколько эффективна назначенная терапия.
Как сдавать анализ
Назначить проведение теста может терапевт, онколог, хирург, гастроэнтеролог. Перед сдачей нужна предварительная подготовка. Врачи дают следующие рекомендации. За 72 часа до сдачи анализа исключите из меню железосодержащие продукты, а также томаты и овощи и фрукты, имеющие зеленый цвет. Не стоит употреблять мясо или рыбу, поскольку в них есть гемоглобин.
За неделю прекратить прием медикаментов, таких как аспирин, слабительные, железосодержащие таблетки, нестероидные противовоспалительные лекарства. Если приостановить медикаментозную терапию нет возможности, то врачу нужно сообщить о принимаемых препаратах.
Не употреблять продукты, изменяющие окраску кала. Сбор материала должен проводиться до диагностических манипуляций в области пищеварительного тракта. Не рекомендуется делать клизму или принимать слабительные препараты, чтоб ускорить получение образца для анализа.
Нельзя собирать образец во время менструации. Если проводилась рентгенодиагностика, то анализ можно сдавать только спустя 2-3 дня.
Если у обследуемого есть заболевания пародонта, при котором выраженная кровоточивость десен, то за сутки до сбора кала не советуют чистить зубы, поскольку попавшая в желудок кровь способна выдать положительный результат.
Брать материал нужно с трех разных сторон каловых масс. Вероятен недостоверный ответ, если в образец попадет вода или моча. Для того чтоб это исключить рекомендуется постелить клеенку на унитаз. Образец для проверки нужно поместить в пластиковый контейнер (его можно приобрести в аптеке) и принести в лабораторию в ближайшие 2-3 часов.
Что значит, если результат положительный?
Анализ на скрытую кровь положительный, если развивается патология, при которой в просвет желудка или кишки попадает некоторый объем крови. То есть присутствует болезнь, для которой характерно воспаление слизистой и ее перфорация.
Положительный ответ говорит о развитии следующих патологий:
- колоректальный рак;
- опухоль;
- язвенная болезнь;
- язвенный колит;
- туберкулез кишечника;
- паразиты, травмирующие слизистую кишечника;
- изменения вен пищевода из-за цирроза или тромбофлебита селезеночной вены;
- эрозивный эзофагит;
- болезнь Рандю-Ослера;
- геморрой.
У маленьких детей также могут увидеть кровь в кале. Довольно часто это связано с непереносимостью ребенком коровьего молока. Если кроха находится на грудном вскармливании, то даже употребление матерью молока, сливочного масла, сметаны может спровоцировать кровотечение.
Кровотечение у малыша может быть вызвано дисбактериозом, амебиазом, колитом, дизентерией. Одной из причин присутствия крови в кале это трещины анального отверстия, возникшие в результате прохождения слишком твердых каловых масс. Это бывает, если ребенок мало употребляет жидкости.
Опухоли в толстой кишке несильно, но постоянно кровоточат с момента образования. Если кровотечение стало обильным, то оно обнаружится и при копрограмме. Анализ на скрытую кровь помогает увидеть симптомы рака в ранний период, а это увеличивает шансы благоприятного исхода болезни. Положительный анализ на скрытую кровь будет из-за кровотечения из носа или десен, глотки.
Как определяют наличие крови в кале
Во время исследования применяются химические вещества, которые при контакте с эритроцитом под действием окисления изменяют окраску. Метод Грегерсена позволяет увидеть даже малое количество гемоглобина. Бензидин окрашивает железо в синий цвет.
С учетом скорости окрашивания и его интенсивности устанавливают слабоположительную (+), положительную (++ или +++) и резкоположительную (++++) реакцию. При применении бензидина удается установить кровопотери свыше 15 мл/сут, что часто дает ложноположительные результаты.
Иммунохимический анализ кала считается более точным. В нем используются антитела к гемоглобину человека, поэтому нет нужды соблюдать диету. Тест высокочувствительный, он выявит 0,05 мг гемоглобина на грамм кала (при 0,2 мл/г кала считается тест положительным).
Этот способ позволяет обнаружить опухолевые образования в толстом кишечнике, но не выявляет кровотечение из пищевода или желудка. В 3% случаев тесты дают положительный результат при отсутствии новообразования в толстом кишечнике.
Причины ложноположительного и ложноотрицательного результата
В норме в кале отсутствует кровь, поэтому если нет патологии, провоцирующей кровотечение в пищеводе, желудке или кишечнике, то результат анализа будет отрицательным. При некоторых обстоятельствах анализ кала на скрытую кровь дает ложноположительный или ложноотрицательный результат.
Так, часто при исследовании не выявляется кровь в случае образования в толстом кишечнике, поэтому для подтверждения колоректального рака и полипов, применяется колоноскопия или гибкая сигмоидоскопия.
Ложноположительный результат может быть получен, если отсутствовала подготовка к исследованию, если есть кровоточивость десен или у пациента часто случаются носовые кровотечения. Кровь в кале будет если нанесена слизистой оболочке травма, например, пациент порезал пищевод рыбной костью.
Чаще проводится анализ именно на наличие железа в каловых массах, поэтому даже съеденное вчера яблоко, может окрасить образец, что будет трактоваться как присутствие крови. Чтобы исключить ложноположительные или ложноотрицательные результаты рекомендуется проводить диагностику трижды (образцов трех последовательных дефекаций) и выполнять все рекомендации по подготовке к исследованию и сбору материала.
Если анализ оказался неинформативным, то врач назначает проведение аппаратного исследования — колоноскопию. Оно заключается в осмотре поверхности толстой кишки при помощи эндоскопа, введенного через анальное отверстие.
Такая диагностика позволит увидеть точную локализацию просвета. Для определения состояния слизистой пищевода или желудка применяется эндоскопия, при которой гибкая трубка вставляется через рот. Для того чтоб исключить ошибочный результат рекомендуется сдавать анализ трижды.
Если исследование дало отрицательный результат, то врач не станет исключать язвенную болезнь или раковое поражение органа пищеварительной системы. На основании одного лишь анализа на скрытую кровь в кале нельзя поставить диагноз, он лишь означает, что присутствует патология и совместно с клиническими проявлениями болезни позволяет установить предварительный диагноз.
источник: jktguru.ru
Кал, как и моча, является конечным продуктом жизнедеятельности человека. Он формируется в толстом кишечнике в результате целого ряда биохимических процессов. В состав испражнений входит вода, непереваренные остатки пищи, побочные продукты обмена веществ, бактерии и так далее.
Не стоит недооценивать исследование кала. Порой именно этот анализ позволяет выявить у взрослых и детей патологию пищеварительного тракта, болезни печени, поджелудочной железы. Назначают это обследование не только с целью диагностики заболеваний, но и для контроля проводимого лечения.
Что показывает копрограмма (анализ кала):
- исследование физических и химических свойств кала (цвет, консистенция);
- микроскопия материала;
- бактериологическое исследование (обнаружение болезнетворных микробов и анализ кишечной микрофлоры);
- обнаружение яиц гельминтов;
- выявление в кале скрытой крови.
Как подготовиться к анализу кала?
Предварительная подготовка к сдаче материала у детей и взрослых в норме длится 3-4 дня. Направлена она на очищение кишечника и предотвращение попадания в кал остатков пищи, мышечных и растительных волокон. При соблюдении специальной подготовки лаборанты смогут выявить даже небольшую степень нарушения эвакуаторной и переваривающей функции пищеварительного тракта.
Суть подготовки заключается в соблюдении специальной диеты с определенным содержанием белков, жиров и углеводов. Для этой цели подходит два вида диет: по Певзнеру и по Шмидту.
Режим питания по Певзнеру
Он предусматривает употребление в пищу черного и белого хлеба, мяса (варенного или жаренного), квашеной капусты, рисовой и гречневой каш, свежих яблок, картофеля (в любом виде), сливочного масла. Общая энергетическая ценность составляет около 3000 ккал в сутки.
Диета по Шмидту
Она является щадящей. Рекомендуется кушать 5 раз в день, преимущественно молочные продукты (молоко, сливочное масло), пару яиц, мясо, картофель, овсяную кашу (слизистый отвар). Суточная калорийность должна ограничиваться 2200-2400 ккал.
Кал на скрытую кровь
- Перед исследованием кала на скрытое кровотечение пациентам не рекомендуется употреблять в пищу продукты, которые могут вызвать ложноположительную реакцию на кровь. К ним относятся: все разновидности зеленых овощей (огурец, капуста), рыба, мясо, яйца, помидоры.
- Также больным следует воздержаться от приема медикаментов, содержащих железо (феррум-лек, феррумбо).
В случае, когда необходимо срочно сдать анализ или соблюдать диету не позволяет состояние здоровья, рекомендуется хотя бы за сутки не употреблять алкогольные напитки, чай, кофе.
Категорически запрещается перед проведением обследования
- делать очистительную и сифонную клизму;
- принимать лекарства, влияющие на перистальтику кишечника (слабительные или противодиарейные);
- вводить свечи или другие формы лекарственных препаратов в задний проход;
- применять медикаменты, изменяющие окраску материала (сульфат бария, препараты висмута).
Как сдавать копрограмму?
Материал нужно собирать в чистую посуду после утреннего самостоятельного опорожнения кишечника. Для исследования хватит 10-15 г кала. В редких случаях врач может назначить суточное исследование испражнений. В таком случае больному необходимо собирать кал в течение 24 часов.
Если пациент страдает длительными запорами и не может самостоятельно опорожниться, рекомендуется провести массаж толстой кишки. Если эта процедура не принесла результатов, больному следует сделать очистительную клизму. В этом случае из промывных вод отбирают твердый кусочек испражнений.
Методика сбора анализа:
- утром после сна пациенту рекомендуется испражниться в горшок или судно
- затем специальной палочкой или шпателем отбирают небольшое количество кала в чистую сухую банку и плотно закрывают крышкой.
- анализ желательно сразу же доставить в лабораторию. Крайний срок – 8-10 часов. Спустя это время материал может испортиться и стать непригодным для обследования.
- хранение кала осуществляется при температуре 3-6 0 С.
При исследовании на яйца глистов материал должен быть совершенно свежим, то есть, доставлен в лабораторию в теплом виде.
Забор кала при бактериологическом обследовании производится с помощью лаборанта. Больному предлагают лечь на правый бок или в положении стоя наклониться вперед. Лаборант разводит ягодицы пациента и вводит в анальное отверстие металлическую петлю с намотанным на нее ватным тампоном. Введение должно осуществляться вращательными движениями, очень аккуратно, чтобы не повредить слизистую оболочку ануса. Выводят петлю также осторожно, помещая затем в стерильную пробирку.
источник: zdravotvet.ru
Анализ на кровь в кале | Медик03
Анализ кала на скрытую кровь — один из лабораторных методов диагностики, позволяющих выявить скрытые кровотечения пищеварительного тракта.
Пожалуй, почти каждому взрослому человеку известно: если в кале появилась примесь крови, это может быть симптомом целого множества опасных заболеваний, поэтому при обнаружении подобного симптома необходимо сразу же обратиться к врачу.
Но не все знают о том, что некоторые заболевания системы пищеварения на первых этапах протекают бессимптомно, хотя уже в это время в кале могут быть обнаружены частицы крови путем проведения специального исследования. Размер таких частиц пока еще настолько мал, что увидеть их невооруженным взглядом практически невозможно. Именно поэтому врачи назначают анализ кала на скрытую кровь при подозрении на развитие некоторых заболеваний.
Анализ кала на скрытую кровь входит в число наиболее распространенных лабораторных исследований. Его проводят с целью выявления скрытого кровотечения из желудка, кишечника и других органов системы пищеварения.
Показания к проведению
Анализ кала на скрытую кровь может быть назначен в следующих случаях:
- при появлении болей в животе неясного происхождения;
- в случае длительной тошноты, рвоты, изжоге;
- при наличии постоянного жидкого или кашицеобразного стула;
- в случае чрезмерной потери массы тела;
- при выявленных нарушениях в работе желудочно-кишечного тракта (ЖКТ);
- при гельминтозе;
- если у пациента диагностирована язва желудка;
- для оценки степени повреждения слизистой оболочки органов ЖКТ.
Поэтому, если врач настаивает на проведении указанного анализа, не следует отказываться, ведь указанное обследование, в отличие от некоторых других методов лабораторной диагностики, не представляет абсолютно никакой опасности для здоровья пациента и относится к числу совершенно безболезненных методов.
Особенности подготовки
Чтобы результат анализа был максимально точным, пациент должен выполнить все указания относительно подготовки к анализу и порядку его выполнения.
Спектр предъявляемых требований — достаточно несложный, но обширный:
- за три дня до предполагаемого времени взятия образца кала для анализа исключить из рациона питания мясо, субпродукты, рыбу, томаты, зеленые овощи и фрукты (яблоки, перец, шпинат, фасоль и др.);
- отказаться от приема и использования слабительных препаратов и средств;
- за 7-10 дней исключить прием медикаментов, которые влияют на перистальтику кишечника или могут открашивать кал в другой цвет;
- не проводить рентгенологические обследования за три дня до процедуры;
- накануне исследования следует воздержаться от чистки зубов, так как мельчайшие частички крови с поврежденных щеткой десен могут попасть в пищеварительный тракт и исказить результаты исследования;
- нельзя делать клизмы ни накануне, ни во время взятия материала для анализа. Процесс опорожнения кишечника должен осуществляться исключительно естественным путем;
- сбор кала осуществляется в специальный контейнер с плотной крышкой (можно приобрести в аптеке);
- для анализа можно использовать одни фрагмент кала объемом не менее одной чайной ложки, но будет лучше, если пациент соберет в контейнер несколько фрагментов из общего объема кала;
- следует избегать случайного попадания мочи в образец кала;
- женщинам следует воздержаться от проведения данного анализа в дни месячных;
- желательно доставить образец в лабораторию в течение трех часов после дефекации.
Если результат положительный?
В норме в течение суток вместе с калом у человека может выделяться до 1-2 мл крови (1-2 мг Hb на 1 г кала), что обычно не обнаруживается лабораторными тестами. Если количество выделяемой крови не превышает эту норму, то результат обследования является отрицательным, то есть кровотечение из органов пищеварительного тракта отсутствует.
Если результат анализа — положительный, это может свидетельствовать о наличии следующих заболеваний:
- язва желудка и 12-перстной кишки;
- болезнь Крона (поражение верхних отделов кишечника);
- неспецифический язвенный колит;
- полипы органов пищеварительного тракта;
- гельминтоз;
- злокачественные поражения органов ЖКТ;
- геморрой;
- трещина заднего прохода;
- туберкулез кишечника;
- носовые кровотечения;
- заболевания полости рта: пародонтоз, стоматит;
- кровотечение из варикозно расширенных вен пищевода.
При оценке результатов исследования следует учитывать тот факт, что в некоторых случаях результат может быть ложноположительным или ложноотрицательным.
Так, ложноотрицательный результат (т.е. если результаты анализа показывают, что у человека нет кровотечения, а на самом деле оно имеется), может быть в том случае, если кровотечение из органов ЖКТ не является постоянным, а возникает периодически (например, при наличии полипов).
Ложноположительный результат может быть получен, если пациент случайно травмировал слизистую оболочку ротовой полости или язык накануне исследования и не заметил этого, если употребил в пищу железосодержащие продукты (например, яблоки), несмотря на предостережения врача.
Таким образом, при получении отрицательного результата, если симптомы заболевания не исчезают, следует сдать анализ повторно или использовать другие методы обследования. Если результат положительный, то пациент тем более должен обследоваться более тщательно, чтобы врач смог установить точную причину появления крови в кале.
Обратите внимание!
Наличие таких симптомов как:
- запах изо рта
- боли в животе
- изжога
- понос
- запор
- тошнота, рвота
- отрыжка
- повышенное газообразование (метеоризм)
Если у вас есть хотя бы 2 из этих симптомов, то это свидетельствует о развивающемся
гастрите или язве.
Эти заболевания опасны развитием серьезный осложнений (пенетрация, желудочное кровотечение и т.д.), многие из которых могут привести к
ЛЕТАЛЬНОМУ
исходу. Лечение нужно начинать уже сейчас.
Читайте статью о том, как женщина избавилась от этих симптомов победив их основную причину.Читать материал…
- Расшифровка анализов онлайн — мочи, крови, общий и биохимический.
- Что значат бактерии и включения в анализе мочи?
- Как разобраться в анализах у ребенка?
- Особенности проведения МРТ-анализа
- Специальные анализы, ЭКГ и УЗИ
- Нормы при беременности и значения отклонений..
Расшифровка анализов
Желудочно-кишечное кровотечение может обернуться весьма трагично, если своевременно его не выявить. В случае с выраженным красным калом у врачей не возникает сомнений насчет наличия внутренних патологических процессов, но некоторые заболевания протекают почти бессимптомно.
И только мельчайшие частички крови в каловых массах выступают признаком расстройства деятельности ЖКТ. Проведение такого исследования требует соблюдения ряда правил для исключения ложного результата.
Виды анализа кала на скрытую кровь
Повреждения в пищеварительном тракте могут локализоваться как в верхних, так и в нижних отделах. Если кровотечение открылось в желудке или двенадцатиперстной кишке, то каловые массы приобретают темно-красный цвет, а в толстом кишечнике ― ярко-красный.
Но не при каждом расстройстве появляется такой стул. Зачастую мелкие язвы и воспаления лишь иногда кровоточат. Известны случаи развития опухоли, единственным симптомом которых выступает только небольшая примесь гемоглобина в кале.
Лабораторное исследование дает возможность определить наличие крови в кишечнике. Анализы осуществляют двумя способами:
- Метод Грегерсена (бензидиновая проба).
- Иммунохимический метод.
Метод Грегерсена показывает наличие гемоглобина даже очень низкой концентрации. В этом заключается и достоинство, и недостаток анализа. В присутствии бензодина железо транспортной молекулы окисляется под воздействием перекиси водорода и приобретает синий цвет.
Реакция идет на гемоглобин как человеческий, так и посторонний (содержащийся в мясных продуктах). Поэтому для уточнения результатов врачи нередко прибегают ко второму методу.
Иммунохимический анализ кала более точный. Он основывается на специфичном воздействии антигенов на антитела, свойственных конкретному человеку. Метод применяют обычно при инфекционных заболеваниях, но на первичную цель исследования ― определение крови в кале ― это никак не влияет.
И если дополнительно удастся установить тип патогенных микроорганизмов, спровоцировавших воспаление кишечника, диагностическое мероприятие можно будет считать даже перевыполненным. Недостаток иммунохимического анализа заключается в его длительности: только через 2 недели врачи устанавливают диагноз.
Когда назначается анализ?
Сдача анализов кала на скрытую кровь не назначается просто так. Обычно пациент обращается с жалобами на боль в животе или недомогание. Общие показания к проведению теста заключаются в следующем:
- периодические или постоянные боли в животе;
- регулярная тошнота, рвота, диарея или изжога;
- хроническое расстройство стула;
- быстрое снижение массы тела без видимых причин;
- для подтверждения диагноза (при язве, гастрите и т.д.).
По сути, цель анализа заключается в выявлении повреждения стенок кишечника и желудка. И если врач настаивает на подробном изучении каловых масс, пациенту не следует отказываться.
Тест проводится без каких-либо внутренних вмешательств, поэтому больно не будет. Однако высокая чувствительность реактивов требует особой подготовки пациента.
Подготовка к анализу кала на скрытую кровь
Любое исследование имеет погрешность. Но чтобы результаты получились достоверными, необходимо соблюдать диету перед анализом. Прежде всего, придется отказаться от мяса и рыбы, ведь в них содержится гемоглобин.
Также в список ограничений входят железосодержащие и все красные продукты (помидор, свекла и т.д.), которые окрашивают кал даже здорового человека. Диета ― это ключевой момент, но врачи называют и другие требования:
- Отмена медикаментов за 1 неделю до анализа.
- Запрет на слабительные средства (в т.ч. и народные).
- За день до анализа нельзя чистить зубы щеткой (есть риск повреждения десен и искажения результатов).
- Анализ сдают не раньше чем через 3 дня после рентгенологического исследования.
- Исключены клизмы (опорожнение должно быть естественным).
- Женщины сдают анализ в дни, когда нет месячных.
Как правильно взять кал?
Не каждому человеку под силу соблюсти такой запрет, как «нельзя есть». Подготовка к анализу требует обязательного выполнения данного пункта, иначе результат исследования будет весьма сомнительным. Но немаловажным является и сам процесс взятия кала:
- Необходимо подготовить контейнер (продается в аптеке).
- Кал нужен без какой-либо жидкости (воды, мочи и др.). Для этого в унитазе разрешается постелить клеенку.
- После опорожнения чайной ложкой берут 3 фрагмента кала.
- В лабораторию доставить образцы следует в течение 3 часов.
Расшифровка анализа кала на скрытую кровь
Небольшое количество крови все же попадает в кишечник ― 1-2 мл. Это нормально лишь в том случае, если такой объем составляет суточный предел.
Поэтому анализ всегда покажет наличие крови в кале, но можно ли считать столь малое количество признаком расстройства? Нет. Естественные процессы никто не отменял, и во внимание врачи принимают лишь бо́льшие показатели.
Ложные результаты
Чтобы получить достоверные результаты анализа кала на скрытую кровь, подготовку не нужно игнорировать. И если отнестись к данному процессу халатно, то результаты нередко бывают ложными.
При чем как ложноотрицательными, так и ложноположительными. Например, медики точно знают о наличии у пациента полипов в области толстого кишечника, однако анализ не выявляет гемоглобин.
Это происходит из-за того, что подобные новообразования кровоточат отнюдь не постоянно, а лишь периодически. Но и отрицать наличие полипов будет глупо, особенно в случае обнаружения с помощью эндоскопа.
Ложноположительный результат ― тоже частое явление. Если пациент пренебрег правилами подготовки и взятия кала, то вполне возможно, что исследование покажет наличие высокого уровня гемоглобина при отсутствии внутреннего кровотечения. Анализ обычно проводят по методу Грегерсена, который чувствителен именно к железу.
Скушав лишь 1 яблоко за день до взятия кала, человек попросту исказит результаты. К тому же кровь может попасть в кишечник вследствие травмы десны зубной щеткой.
Таким образом, несоблюдение правил даст врачам повод для выполнения колоноскопии, суть которой заключается во введении зонда через анальное отверстие. Так уж лучше подвергнуться столь неприятной процедуре не из-за собственной халатности!
Что означает положительный результат?
И все же анализ может показать наличие высокого уровня гемоглобина в каловых массах. В этом случае колоноскопия назначается для уточнения диагноза, ведь причин кровотечения бывает множество:
- язва;
- воспаление в любых отделах;
- болезнь Крона;
- геморроидальные узлы;
- гельминтоз;
- туберкулез;
- трещина кишки;
- добро- или злокачественная опухоль (полипы, рак, киста и т.д.).
Нередко кровь попадает в кишечник из полости рта или носа. Однако повреждения сосудов в легкодоступных участках тела легко определяются соответствующими врачами (стоматолог и отоларинголог).
Анализ кала на скрытую кровь ― это важный диагностический инструмент. Иногда только примеси гемоглобина указывают на патологический процесс в кишечнике. И если нарушения выявить своевременно, то и лечение не заставит себя ждать.
Медики рекомендуют хотя бы 1 раз в год сдавать такой анализ, особенно в свете участившихся случаев кишечных заболеваний.
Зачем проводят анализ для обнаружения скрытой крови в кале
Когда сдают тест
- боль в животе, которая постоянна или возникает периодически;
- тошнота и рвота;
- изжога;
- опорожнения по консистенции отличаются от нормы (кашицеобразные);
- ложные позывы к дефекации;
- частые запоры;
- диарея;
- потеря веса, отсутствие аппетита;
- гипертермия.
Если кровотечение не сильное, то заметить кровь в каловых массах без специальных реагентов невозможно
Как сдавать анализ
Что значит, если результат положительный?
- колоректальный рак;
- опухоль;
- язвенная болезнь;
- язвенный колит;
- туберкулез кишечника;
- паразиты, травмирующие слизистую кишечника;
- изменения вен пищевода из-за цирроза или тромбофлебита селезеночной вены;
- эрозивный эзофагит;
- болезнь Рандю-Ослера;
- геморрой.
В отдельных случаях опухоль проявляется только выделением малого объема крови с калом
Если у ребенка есть непереносимость лактозы, то нужно очень тщательно подбирать искусственную смесь.
Как определяют наличие крови в кале
Причины ложноположительного и ложноотрицательного результата
Как правило, ложноположительный результат анализ дает, если пациент проигнорировал рекомендации врача и не придерживался диеты
Если анализы дважды показывают большое количество гемоглобина в каловых массах, то они считаются достоверными.
Анализ кала скрытая кровь что это значит
При нормальной работе органов пищеварительной системы в каловых массах человека не должно находиться примесей крови. Несмотря на это существует ряд заболеваний ЖКТ, когда появление небольшого количества крови – это прямой симптом патологии, требующей срочного медикаментозного лечения, а в некоторых случаях даже хирургического вмешательства (обострение язвенной болезни, завороток кишок, некроз тканей кишечника). Само определение скрытой крови в стуле – это специфическое состояние органов пищеварения, когда вооруженным глазом кровянистые выделения увидеть не удается и даже использование микроскопа не позволяет на все 100% диагностировать присутствие данной биологической примеси. Только с помощью специальной методики исследования в лабораторных условиях, медики обнаруживают клетки крови и получают первые признаки того или иного заболевания ЖКТ.
Что показывает исследование кала на скрытую кровь?
Данный вид диагностики помогает идентифицировать наличие или полное отсутствие кровеносных частиц в фекалиях непосредственно после опорожнения кишечника. При этом доктора имеют возможность установить, какая концентрация гематогенного составляющего в кале.
Исходя из этого можно сделать выводы, присутствует у человека сильное кровотечение внутренних органов, попадает кровь в стул часто или периодически под воздействием негативных факторов.
На основании полученных информационных данных начинается подготовка к выставлению диагноза. Также, получив на руки результаты биохимического исследования каловых масс на предмет наличия в них скрытой крови, лечащий врач определяет перечень дополнительных диагностических процедур, которые необходимо пройти пациенту, дабы максимально точно и за предельно короткий период времени выявить причину подтекания крови в полость органов ЖКТ. Кроме того, с помощью этого анализа удается понять, с какого именно сосуда с нарушенной целостностью идет выброс кровеносного русла (капилляры, артерия, вена).
Какие виды исследований для этого существуют, плюсы и минусы?
Для проведения данного диагностического обследования фекалий с определением в них содержания скрытой крови, применяются два наиболее информативных и эффективных способа, а именно.
Иммунохимическая проба
Анализ кала на скрытую кровь показывает патологические изменения в нижнем отделе пищеварительной системы, если уже после прохождения пищи области толстого кишечника, происходит выделение кровеносных частиц через нарушенную целостность слизистой оболочки кишки.
Достоинство данного вида исследования заключается в том, что человеку не требуется придерживаться какого-либо диетического питания, отказываться от продуктов, содержащих большое количество такого минерала, как железо (мясо, яблоки, колбасы, рыба).
Иммунохимический анализ на скрытую кровь считается положительным, если в кале пациента обнаруживается гематоглобулин человека. Это прямой показатель того, что в пищеварительный тракт в небольших объемах поступают частички крови, формируя скрытое присутствие в кале. После этого начинается более подробное изучение органов брюшной полости, ткани которых имеют возможное нарушение целостности. Также обследуются магистральные сосуды, расположенные в непосредственной близости к органам ЖКТ.
Реакция Грегерсена
Данный вид диагностики в медицинской терминологии еще именуется, как бензидиновая проба. Применяется для выявления внутренних кровотечений во всех отделах пищеварительной системы. Для реализации данного лабораторного метода изучения каловых масс пациента, применяются химические реактивы. Плюс методики в том, что она с 95% вероятностью позволяет определить, в какой именно части желудочно-кишечного тракта сосредоточилась патология, вызывающая подтекание крови в пищеварительную систему.
Минус диагностики состоит в излишней чувствительности химических компонентов к большому количеству веществ, содержащих в своем составе оксид железа. Поэтому человеку за несколько дней до проведения процедуры, приходится придерживаться строгой диеты, из которой полностью исключаются все продукты питания, содержащие железо. С этой целью врач-гастроэнтеролог или специалист, занимающийся биохимическим изучением каловых масс с помощью пробы Грегерсена, составляет пациенту подробное меню с разрешенными и запрещенными блюдами.
Исходя из этого и сравнивая две вышеуказанные методики большинство специалистов в области лечения пищеварительных патологий, связанных с внутренними кровотечениями, приходят к единому выводу, что иммунохимический метод исследования каловых масс является наиболее действенным и таковым, который позволяет гастроэнтерологу получить максимально достоверную информацию о биохимическом составе стула и локализации возможных очагов с разрушенной целостностью слизистой оболочки кишечного тракта, а также более плотных слоев эпителиальных тканей. Реакция Грегерсена выявляет в кале гематоглобулин не хуже, но слишком высока степень погрешности.
Показания к сдаче анализа
В большинстве случаев прямые показания для выполнения биохимического исследования фекалий на предмет наличия в них скрытой крови, заключаются в присутствии у пациента следующих сопутствующих симптомов, указывающих на одно из возможных заболеваний ЖКТ:
- устойчивый болевой синдром в брюшной полости, который не имеет конкретной локализации в плане одного из органов системы пищеварения;
- частое и беспричинное возникновение диареи, либо же постоянная дефекация сильно разжиженными каловыми массами;
- диспептические расстройства, проявляющиеся в форме затяжной изжоги, избыточном газообразовании, тошноте, рвоте, отсутствии аппетита;
- различного рода нарушения по части переваривания пищи и ее усвоения с расщеплением на питательные вещества;
- резкое снижение массы тела на фоне того, что человек продолжает питаться в тех же самых объемах, а энергетическая и биологическая ценность продуктов остается неизменной;
- стандартная клиническая диагностика кала не обнаруживает факт внутреннего кровотечения, хотя у пациента имеется целый ряд других признаков, являющихся прямым указателем попадания крови в полость ЖКТ.
Обязательным условием для тестирования кала на скрытую примесь крови является наличие у человека таких заболеваний, как язвенная болезнь желудка, онкологические процессы в прямой кишке, коллит, сопровождающийся эрозией слизистой оболочки кишечника. Положительная реакция на скрытую кровь в кале говорит о том, что в пищеварительном тракте пациента нарушена целостность тканей.
Как сдавать анализ – подготовка к сдаче кала на скрытую кровь
Первым шагом к проведению качественной диагностики является выполнение подготовительных процедур, обеспечивающих стабильную микрофлору кишечника, а также очищение его полости от возможных частиц пищи, способных негативным образом повлиять на результаты анализов.
Для пациентов, которым предстоит пройти тест на реакцию Грегерсена, необходимо соблюдать следующие правила взятия кала на скрытую кровь:
- За 3 суток до начала исследования исключить из своего рациона мясо, рыбу и разнообразные морепродукты. Под запретом находятся спиртные напитки, витаминные и минеральные комплексы, лекарственные препараты, содержащие оксид железа.
- Не проходить диагностику женщинам в период менструального цикла. Несоблюдение этого предостережения приведет к отображению искаженных данных и случайному попаданию капелек крови в фекалии.
- За 7 суток до сдачи каловых масс на обследование, не использовать ректальные суппозитории и промывающие клизмы.
- С осторожностью подходить к вопросам гигиены ротовой полости, чтобы не было случайного повреждения десен грубой щетиной зубной щетки. Даже незначительное попадание капиллярной крови из ротовой полости в желудок, способно показать положительный результат в плане теста на скрытую кровь.
Правильная сдача биологического материала для исследования каловых масс, заключается в том, что человек самостоятельно приобретает стерильную емкость в аптеке или ему ее выдают в медицинском учреждении по месту прохождения обследования. В фекалии не должны попасть никакие посторонние примеси в виде мочи и прочих выделений. Сразу же после дефекации образцы стула направляются в лабораторию для исследования и биохимического анализа. Предварительный сбор фекалий лучше также выполнять в стерильный горшок или баночку. Перенос кала из унитаза является недопустимым.
doctorzkt.com
В том случае, если тест на скрытую кровь отрицательный
Полипы и опухоли на ранней стадии кровоточат периодически, так что может случиться, что первый тест, даже при наличии поражения отрицательный. Поэтому чтобы увеличить вероятность выявления имеющегося кровотечения, рекомендуется периодически повторять тест. Оптимальная частота, учитывая медленное развитие полипов и их злокачественную трансформацию, — раз в два года с использованием иммунохимического теста и ежегодно с Гваяковым тестом
ВНИМАНИЕ: при отрицательном тесте все равно необходимо пойти к врачу, если имеются стойкие запоры или постоянная диарея, наличие красного или черного кала; ощущение дискомфорта в прямой кишке после дефекации; внезапное похудение без основания, ночные боли в животе
Тест на скрытую кровь проводится только через 3-5 дней после окончания менструации
При запорах тест нас крытую кровь не исключает прием слабительных.
При красном и черном стуле (видимых глазом кровотечениях) выполнять тест на скрытую кровь не логично.
При положительном тесте на скрытую кровь вместо колоноскопии можно выполнить альтернативные тесты, но колоноскопия предпочтительней, поскольку позволяет выполнить биопсию и удаление полипов — полипэктомию.
- Кал собрать утром
- Сбор фекалий осуществить так, чтобы они не попали в воду. Желательно собрать в чистое, сухое судно, либо закрыть унитаз пленкой так, что кал оказался на пленке. Моча нет должна попасть в кал!
- Образцы нельзя собирать в течение трех- пяти дней после окончания менструации, при геморроидальном кровотечении. Алкоголь, аспирин и другие противовоспалительные препараты могут вызвать раздражения кишечника (в том числе толстой кишки) и дать скрытое кровотечение Сбор образца осуществляется специальным шпателем в банку, с 3-4 разных точек поверхности кала.
- В том случае, если необходимо для исследования три образца кала, то их необходимо собирать из трех дефекаций, пусть даже в один и тот же день.
- Кал можно доставить в лабораторию в течение нескольких часов
- Если необходимо собрать три образца, то каждый собранный образец храниться в холодильнике, а затем одновременно доставляется в лабораторию
- После отбора образцы на скрытую кровь устойчивы максимум 7 дней. Но следует учитывать требования лаборатории.
Итак, тест на скрытую кровь в кале имеет фундаментальное значение при скрининге колоректального рака, так как опухоли протекает бессимптомно, но могут быть обнаружены и вовремя пролечены только благодаря их минимальному даже периодическому кровотечению,
Скрытые кровотечения часто проявляются клинической картиной анемии (гипохромная, микроцитарная анемия). Поэтому наличие клинической картины анемии должны быть проведены целевые исследования (гастроскопия, колоноскопия и т.д.) и кал на скрытую кровь.
biohimik.net
Зачем проводят анализ для обнаружения скрытой крови в кале
Когда сдают тест
- боль в животе, которая постоянна или возникает периодически;
- тошнота и рвота;
- изжога;
- опорожнения по консистенции отличаются от нормы (кашицеобразные);
- ложные позывы к дефекации;
- частые запоры;
- диарея;
- потеря веса, отсутствие аппетита;
- гипертермия.
Как сдавать анализ
Что значит, если результат положительный?
- колоректальный рак;
- опухоль;
- язвенная болезнь;
- язвенный колит;
- туберкулез кишечника;
- паразиты, травмирующие слизистую кишечника;
- изменения вен пищевода из-за цирроза или тромбофлебита селезеночной вены;
- эрозивный эзофагит;
- болезнь Рандю-Ослера;
- геморрой.
Как определяют наличие крови в кале
Причины ложноположительного и ложноотрицательного результата
jktguru.ru
Анализ кала на скрытую кровь – анализ кала, проводимый в целях выявления скрытого кровотечения из различных отделов желудочно-кишечного тракта. Он позволяет обнаружить измененный гемоглобин эритроцитов даже в том случае, когда сами эритроциты при микроскопическом исследовании кала не определяются.
Синонимы русские
Исследование кала на скрытую кровь.
Синонимы английские
Occult blood test, fecal occult blood test.
Метод исследования
Проба Грегерсена (бензидиновая проба).
Какой биоматериал можно использовать для исследования?
Кал.
Как правильно подготовиться к исследованию?
- Исключить из рациона мясо, рыбу, зеленые овощи, томаты в течение 72 часов до исследования.
- Исключить прием слабительных препаратов, введение ректальных свечей, масел, ограничить прием медикаментов, влияющих на перистальтику кишечника (белладонны, пилокарпина и др.) и на окраску кала (железа, висмута, сернокислого бария), в течение 72 часов до сбора кала.
- Исследование проводить до выполнения ректороманоскопии и других диагностических манипуляций в области кишечника и желудка.
Общая информация об исследовании
Анализ кала на скрытую кровь является крайне важным лабораторным исследованием при диагностике именно скрытых кровотечений из различных отделов ЖКТ. Такие кровотечения – один из ранних симптомов целого ряда тяжелых заболеваний ЖКТ, в том числе онкологических. При скрытом кровотечении, даже длительно существующем, определить наличие крови в кале как визуально, так и микроскопически очень трудно, а чаще всего просто невозможно.
При обильных кровотечениях из различных отделов ЖКТ кровь настолько изменяет внешний вид кала, что ее наличие часто можно определить визуально. Если кровотечение из нижних отделов кишечника (толстая кишка, прямая кишка), то кровь будет алого цвета, возможно, в виде сгустков или примесей. Если же источник кровотечения – в верхних отделах ЖКТ (часть тонкого кишечника, пищевод, желудок), то кал превращается в черный, «дегтеобразный» за счет взаимодействия крови и особых ферментов, продуцируемых в данных отделах ЖКТ. Как правило, если имеются визуальные признаки ЖКТ-кровотечения, то ситуация острая и требует экстренных мер (неотложной помощи). Однако при менее выраженных нарушениях целостности слизистой оболочки ЖКТ, с вовлечением в процесс малого количества сосудов, цвет и консистенция кала не меняются, но эритроциты в кале будут видны при микроскопическом исследовании. Если же микроскопически эритроциты не видны, а подозрение на скрытое кровотечение есть, в таком случае и требуется анализ кала на скрытую кровь. Данное исследование осуществляется с помощью измерения количества измененного гемоглобина (а не самих эритроцитов).
Положительная реакция кала на скрытую кровь означает, что у человека имеются болезни желудочно-кишечного тракта, вызывающие нарушение целостности слизистой, когда в просвет желудка или кишки выделяется небольшое количество крови. Это может происходить при язве желудка или двенадцатиперстной кишки, неспецифическом язвенном колите, болезни Крона, полипах, инвазиях гельминтами. Так как опухоли, первичные и метастатические, вызывают поражения слизистой ЖКТ даже при незначительных размерах, исследование используется на первом этапе выявления опухолей ЖКТ. Особенно важно определение скрытой крови при диагностике рака толстой кишки, поскольку именно при опухолях в данном отделе кишечника скрытое кровотечение начинается на самых ранних стадиях.
Кровь в кале может обнаруживаться и при носовых кровотечениях, кровотечениях из десен и глотки, у больных с варикозно-расширенными венами пищевода, эрозивным эзофагитом, при геморрое и других заболеваниях, так что необходимо обязательно учитывать это при оценке результатов анализа.
Достоверность анализа наиболее высока при его повторном проведении. Отрицательные результаты теста не исключают возможного наличия у пациента эрозивно-язвенного или опухолевого поражения ЖКТ. Важно, что результаты должны оцениваться в комплексе с другими инструментальными и лабораторными исследованиями, так как сами по себе не могут быть единственным критерием для постановки диагноза.
Иногда все исследования кала на скрытую кровь ошибочно называют пробой или реакцией Грегерсена, ошибочно – потому что реакция Грегерсена (бензидиновая проба) – это самый распространенный, но не единственный метод обнаружения скрытой крови в кале, моче, рвотных массах и т. д.
Для чего используется исследование?
- Для диагностики заболеваний ЖКТ, сопровождающихся нарушениями целостности слизистой оболочки (язвенная болезнь желудка и двенадцатиперстной кишки, первичные и метастатические опухоли пищевода, желудка, толстого и тонкого кишечника, дуоденального сосочка, туберкулез кишечника, неспецифический язвенный колит, гельминтозы).
- Чтобы оценить степень повреждения слизистой оболочки ЖКТ.
- Чтобы оценить адекватность терапии язвенной болезни желудка, НЯК, болезни Крона, туберкулеза кишечника.
- Чтобы оценить тяжесть заболевания ЖКТ и дать его прогноз.
Когда назначается исследование?
- При болях в животе, изжоге, тошноте, рвоте.
- При частом кашицеобразном стуле, ложных позывах к дефекации, запорах, болях в животе, потере веса, потере аппетита, повышении температуры тела.
- При выявленных опухолях ЖКТ (инструментальными методами) для исключения скрытых кровотечений ЖКТ.
- При обнаружении гельминтов – для оценки повреждения слизистых ЖКТ.
- Если у пациента ранее была диагностирована язва желудка (неспецифический язвенный колит, болезнь Крона, полипоз, туберкулез кишечника).
Что означают результаты?
Референсные значения: отрицательно.
Причины положительного результата:
- колоректальный рак,
- первичные и метастатические опухоли пищевода, желудка, кишечника, дуоденального сосочка,
- язвенная болезнь желудка и двенадцатиперстной кишки,
- неспецифический язвенный колит,
- туберкулез кишечника,
- гельминтозы, травмирующие стенку кишечника,
- расширение вен пищевода при циррозе печени и тромбофлебите селезеночной вены,
- болезнь Рандю – Ослера,
- эрозивный эзофагит,
- носовые кровотечения,
- стоматиты, пародонтоз,
- геморрой.
Отрицательный результат не является диагностически значимым.
Что может влиять на результат?
- При некоторых методах определения скрытой крови употребление в пищу определенных продуктов и препаратов, окрашивающих стул, дает ложноположительную реакцию.
Также рекомендуется
- Копрограмма
- Анализ кала на яйца гельминтов
- Скорость оседания эритроцитов (СОЭ)
- Лейкоцитарная формула
- Общий анализ крови (без лейкоцитарной формулы и СОЭ)
Кто назначает исследование?
Гастроэнтеролог, терапевт, онколог, хирург, врач общей практики.
Литература
- Postgrad Med. 1996 Mar;99(3):253-64.Colorectal cancer screening: present strategies and future prospects.Marshall JB.Department of Internal Medicine, University of Missouri-Columbia School of Medicine.
- Can J Gastroenterol. 2012 Mar;26(3):131-47.Fecal immunochemical tests compared with guaiac fecal occult blood tests for population-based colorectal cancer screening. Rabeneck L, Rumble RB, Thompson F, Mills M, Oleschuk C, Whibley A, Messersmith H, Lewis N.
- Gastroenterology. 1995 Apr;28(4):593-605.An evaluation of the benzidine test for occult blood in the feces.THORNTON GH, ILLINGWORTH DG.
- Tests for Fecal Occult Blood.Authors Ostrow JD.Clinical Methods: The History, Physical, and Laboratory Examinations. 3rd edition. Boston: Butterworths; 199.6 Chapter 98.
helix.ru
Причины желудочно-кишечного кровотечения
К развитию кровотечений из органов желудочно-кишечного тракта (ЖКТ) приводят следующие заболевания:
- язвенная болезнь желудка и двенадцатиперстной кишки;
- полипы, доброкачественные и злокачественные опухоли органов ЖКТ;
- неспецифический язвенный колит;
- болезнь Крона;
- диффузный семейный полипоз;
- геморрой;
- анальные трещины.
Пациентам, страдающим перечисленными заболеваниями, необходимо регулярно сдавать анализ на скрытую кровь в кале.
После достижения 50 лет каждому человеку рекомендуется сдавать анализ кала на скрытую кровь ежегодно, он включен в алгоритм ранней диагностики злокачественных новообразований кишечника, частота заболеваемости которыми в этом возрасте значительно увеличивается. Появление у взрослых лиц, особенно старше 50 лет, положительного теста на скрытую кровь в кале является основанием для дальнейшего углубленного обследования.
Бензидиновая проба
Бензидиновой пробой (реакцией Грегерсена – Адлера) называется химическая реакция, использующаяся для выявления в биологическом материале (моча, желудочный сок, каловые массы) примеси крови. В присутствии крови после внесения реактива цвет исследуемого материала становится ярко-зеленым или синим.
Данный анализ требует подготовки пациента, так как возможно получение ложноположительного результата из-за гемоглобина, содержащегося в мясной пище, некоторых витаминов и других веществ.
Чтобы исключить ложноположительный результат, необходимо соблюдать диету. За 72 часа до исследования из рациона исключают пищу животного происхождения (рыба, птица, мясо) и некоторые овощи (помидоры, кабачки, зелень, зеленые яблоки, хрен, огурцы, цветная капуста, брокколи).
У грудничка причиной ложноположительного результата могут стать трещины сосков у матери. Во время кормления эти трещины кровоточат, а дети заглатывают выделяющуюся кровь вместе с грудным молоком.
Рацион в период подготовки к исследованию:
- молочные продукты (ряженка, кефир, сыр, брынза, творог, молоко);
- каши (овсяная, рисовая, пшенная);
- овощи (картофель, морковь, белокочанная капуста);
- фрукты;
- некрепкий чай, минеральная вода без газа;
- сладости и кондитерские изделия.
Читайте также:
8 эффективных народных средств борьбы с язвенной болезнью
10 причин обострения геморроя
15 растений, проростки семян которых стоит включить в рацион
Иммунохимический анализ кала на скрытую кровь
Старые методы определения скрытой крови в каловых массах, в том числе и бензидиновая проба, реагируют не только на гемоглобин человека, но и на гемоглобин животных, содержащейся в мясных продуктах, поэтому не всегда удается точно определить, что показывает положительный результат – скрытое кровотечение или погрешности питания.
Иммунохимический метод лишен этого недостатка и реагирует именно на кровь человека. Это значит, что он не требует от пациента соблюдения специальной диеты.
Правила сбора материала для анализа на скрытую кровь
За трое суток до сдачи анализа следует прекратить прием препаратов железа и висмута, а за сутки – витамина С (аскорбиновой кислоты) и Аспирина (ацетилсалициловой кислоты).
За 72 часа до исследования необходимо исключить любые диагностические или лечебные манипуляции, затрагивающие органы желудочно-кишечного тракта, т. е. не следует выполнять колоноскопию, ректороманоскопию, рентгеноконтрастное исследование пищеварительного тракта.
За день до сдачи анализа кала на скрытую кровь пациенту не рекомендуют чистить зубы, так как щетка, особенно с жесткой щетиной, может поранить десны, вызвав их кровоточивость.
Кал для исследования необходимо брать только после самостоятельной дефекации. Недопустимо перед исследованием принимать слабительные препараты или ставить клизму, поскольку это искажает результат.
При высокой локализации источника кровотечения каловые массы становятся темного, дегтеобразного цвета, а при низкой кровь в кале обнаруживается визуально.
Необходимо принять меры, чтобы в материал не попала моча или влагалищные выделения, для этого перед дефекацией следует помочиться, а затем подмыться и высушить промежность полотенцем. Во время дефекации не следует чрезмерно натуживаться.
Сразу после дефекации производят забор материала из 3-4 участков каловых масс и помещают их в одноразовый контейнер с крышкой и шпателем, который заранее получают в лаборатории или приобретают в аптеке. Для исследования достаточно 1/3 контейнера. Собранный материал необходимо как можно быстрее доставить в лабораторию.
www.neboleem.net
Скрытая кровь в кале – что это значит?
Некоторое количество крови в норме может присутствовать в испражнениях – не более 2 мг гемоглобина на 1 г кала, при такой предельной концентрации получается, что за сутки здоровый человек теряет с фекалиями до 2 мл крови. Если же кровотечение становится более интенсивным, цвет каловых масс меняется, а его оттенок указывает на локализацию проблемы: чем темнее, тем выше. Например, при кровоточащей язве желудка или двенадцатиперстной кишки кал становится черным, дегтеобразным (мелена), если причина кроется в обострившемся язвенном энтероколите, испражнения приобретут бордовый цвет, а кровоточащие полипы, геморроидальные узлы и злокачественные новообразования в прямой кишке приводят к появлению алых прожилок и пятен на каловых массах. Подобные признаки не могут остаться незамеченными и должны стать поводом к немедленному обращению за врачебной помощью.
Кому показан анализ кала на скрытую кровь?
Такого рода исследование назначается в следующих случаях:
-
Стойкие периодические боли в любой части живота, а также в правом или левом подреберье;
-
Дискомфорт и болезненность во время акта дефекации или после него;
-
Ощущение присутствия инородного тела в прямой кишке;
-
Любые нарушения стула: запоры, поносы, патологическое увеличение или уменьшение объема каловых масс, изменение их цвета, консистенции или запаха, наличие подозрительных включений (пена, слизь, кровь, гной, паразиты или их яйца);
-
Утрата аппетита, резкое снижение массы тела без видимых причин;
-
Тошнота, рвота, отрыжка, изжога, неприятный привкус во рту;
-
Необъяснимое повышение температуры тела;
-
Диагностированные патологии ЖКТ: болезнь Крона, полипоз кишечника, неспецифический язвенный колит, дивертикулез, варикоз пищевода, гельминтоз и так далее – исследование выполняется для определения стадии заболевания или контроля над ходом лечения;
-
Тревожные результаты других, ранее проведенных обследований, например, копрограммы, общего или биохимического анализа крови;
-
Профилактика рака кишечника в возрасте старше 40-50 лет у пациентов с неблагоприятной наследственностью.
Подготовка, диета, сбор и сдача анализа
Исследование на скрытую кровь в кале имеет смысл проводить только при условии тщательного соблюдения правил предварительной подготовки, иначе вероятность получения ложного результата будет очень высока.
Начнем по порядку:
-
Временно отложить анализ необходимо до устранения следующих обстоятельств – стоматит, пародонтоз, носовое кровотечение, менструация, диспепсия, гематурия, обострение геморроя, недавно проведенная диагностическая манипуляция с кишечником (колоноскопия, ректороманоскопия), анальный секс. Все эти факторы с большой вероятностью могут привести к искажению результатов исследования, значит, необходимо решить имеющуюся проблему или подождать несколько дней, в зависимости от ситуации;
-
За неделю до анализа следует отказаться от приема любых медикаментов, нежелательно влияющих на состав кала, а именно – от НПВП (аспирина, ибупрофена, напроксена), барбитуратов, антикоагулянтов, стимуляторов кишечной перистальтики, аскорбиновой кислоты, препаратов и биологически активных добавок, содержащих железо. Если вы постоянно принимаете какие-либо лекарства, и не уверены в том, что они не отразятся на результатах исследования, лучше заблаговременно посоветуйтесь с лечащим врачом;
-
За три дня до анализа нужно начать соблюдать диету – анализ кала на скрытую кровь почти всегда проводится с помощью лабораторных проб, чувствительных к составу пищи, потребляемой пациентом. Поэтому вам придется временно отказаться от любого мяса, птицы, рыбы и субпродуктов – то есть от всего, что может содержать не вашу кровь. Кроме того, рекомендуется исключить из меню некоторые бобы, овощи, фрукты и ягоды, богатые железом и витамином C или сильно влияющие на кишечную перистальтику – например, яблоки, сельдерей, клюкву, апельсины, шпинат, орехи, капусту, томаты, морковь, свеклу, фасоль, сою и чечевицу;
-
За 12 часов до анализа необходимо отложить зубную щетку и отказаться от употребления жесткой пищи, способной травмировать десны и привести к попаданию крови изо рта в пищеварительный тракт.
Как правильно собрать и сдать кал?
Итак, подготовительный этап позади, настало время собирать материал для исследования и везти в лабораторию:
-
Рано утром, до завтрака, совершите наружный туалет интимной зоны с использованием обычного мыла, тщательно ополоснитесь и вытритесь;
-
Произведите дефекацию в заранее подготовленную чистую тару. Процесс должен происходить естественно, без применения клизм или слабительных средств. Брать образец испражнений из унитаза нельзя. Анализ кала на скрытую кровь у ребенка берется из хорошо вымытого горшка, с пеленки или клеенки;
-
Для сбора и транспортировки биоматериала лучше всего подходят специальные стерильные контейнеры с крышкой и ложечкой, которые продаются в любой аптеке. За неимением таковых можно воспользоваться маленькой стеклянной баночкой, предварительно продезинфицировав ее. Наберите понемногу кала из разных частей испражнений, чтобы картина исследования была максимально объективной. Всего достаточно количества, примерно равного 2-3 чайным ложкам;
-
Тару с образцом лучше сразу доставить в лабораторию. Однако допустимо хранение материала в холодильнике в течение не более чем 12 часов. Это особенно удобно в случае с маленькими детьми, чей стул непредсказуем, или людьми, привыкшими опорожнять кишечник перед сном.
Методы проведения исследования: плюсы и минусы
В настоящее время используется четыре основных способа определения скрытой крови в испражнениях:
-
Реакция Грегерсена (бензидиновая проба);
-
Реакция Вебера (гваяковая проба);
-
Иммунохимический анализ кала;
-
Флуоресцентный тест.
Давайте разберемся в сути этих методик, в их преимуществах и недостатках. Забегая вперед, отметим, что в России наиболее часто используются бензидиновая проба и иммунохимический анализ, но являются ли они наиболее точными?
Реакция Грегерсена (бензидиновая проба)
Бензидиновая проба — это простой и быстрый лабораторный тест, позволяющий обнаружить кровь не только в кале, но также, например, в моче, рвотных массах и любой другой биологической жидкости пациента. Это возможно за счет окисления бензидина (парадиаминодифенила) перекисью водорода или бария в присутствии гемоглобина. У бензидиновой пробы есть несколько вариаций, самая часто используемая из них была предложена врачом М. Грегерсеном, потому и носит его имя.
Суть метода в следующем: берут 0,025 г бензидина, к нему добавляют 0,1 г перекиси бария и 5 мл 50% раствора уксусной кислоты, взбалтывают все до полного растворения, наносят несколько капель состава на предметное стекло, по которому тонким слоем размазан исследуемый кал, и наблюдают за реакцией. Если скрытая кровь есть, возникает яркое сине-зеленое окрашивание. Существует альтернативный вариант – готовят насыщенный раствор бензидина в уксусной кислоте и смешивают с 3% раствором перекиси водорода в равных частях. Результат будет выглядеть примерно так же, да и стоимость исследования мало изменится.
Плюсы:
-
Очень высокая чувствительность – 1:100 000;
-
Быстрота получения результата – почти мгновенно;
-
Доступность в любой лаборатории;
-
Невысокая цена.
Минусы:
-
Необходимость в тщательной подготовке к сдаче анализа кала на скрытую кровь по методу Грегерсена, поскольку бензидиновая проба дает положительную реакцию на животный гемоглобин из пищи.
Реакция Вебера (гваяковая проба)
Помимо двух озвученных, у этого способа диагностики есть еще несколько названий: проба Ван-Деена или Альмена-Ван-Деена, гемоккульт-тест. Что любопытно, реакция с применением гваяковой смолы является первой в мировой медицинской практике методикой обнаружения скрытой крови в кале и прочих биологических жидкостях человека. Доктор Ван Деен предложил ее в 1864 году, и она до сих пор активно используется во многих странах.
Суть гваяковой пробы в следующем: берут 3-5 г исследуемого кала, растворяют в уксусной кислоте, при этом выделяется эфирный экстракт, к нему добавляют перекись водорода и настойку гваяковой смолы, а потом наблюдают за изменением цвета реактивов в пробирке. Если состав стал синим, значит, результат анализа на скрытую кровь в кале положительный. Тест повторяют в общей сложности шесть раз: изучают по два образца из биоматериалов, последовательно взятых в течение трех дней.
Плюсы:
-
Оперативность.
-
Доступная цена.
Минусы:
-
Невысокая чувствительность – реакция будет положительной только в случае кровопотери в объеме от 30 мл и более, колоректальный рак обнаруживается в трети случаев, доброкачественные опухоли кишечника – лишь в 15% случаев;
-
Жесткие требования к диете перед анализом кала на скрытую кровь – гваяковая проба чувствительна не только к пероксидазе гема человеческого гемоглобина, но и к пероксидазам других гемов, содержащихся в пище.
Иммунохимический анализ кала
Этот анализ иначе называют иммунологическим или иммунохроматографическим тестом. Методика базируется на реакции, которая возникает при взаимодействии специфических антител с гемоглобином человеческой крови. Ошибки исключены, поскольку антитела не реагируют на гемоглобин животных или железо, содержащееся в некоторых продуктах растительного происхождения. Иммунохимический анализ кала на скрытую кровь появился в арсенале медиков сравнительно недавно и уже прочно там обосновался.
Суть методики в следующем: образец исследуемого кала наносится на тест-полоску или помещается в окошко планшета с реактивами – моноклональными антителами. Если в биоматериале присутствует человеческий гемоглобин, он связывается с антителами, и в контрольной области проступает полоса ярко-розового или фиолетового цвета. Вторая полоса появляется в любом случае – она представляет собой индикатор доброкачественности прибора. Сдача анализа кала на скрытую кровь таким методом очень напоминает проведение теста на беременность – все очень просто, быстро и понятно.
Плюсы:
-
Быстрота и удобство;
-
Отсутствие необходимости в предварительной подготовке и соблюдении диеты;
-
Высокая точность – определяет ранние стадии колоректального рака в 97% случаев.
Минусы:
-
Относительно высокая стоимость;
-
Наличие не в каждой лаборатории;
-
Объективность результатов анализа кала на скрытую кровь только в случае кровотечения в нижних отделах пищеварительного тракта. Агрессивные ферменты, воздействующие на гемоглобин в желудке и тонком кишечнике, приводят его в состояние, негодное для вступления в реакцию с моноклональными антителами.
Флуоресцентный тест
Для полноты картины следует упомянуть о том, что скрытая кровь может быть обнаружена в испражнениях в ходе химической реакции с использованием разрушающих реагентов. Азотсодержащие пигменты порфирины, содержащиеся в молекулах гемоглобина и высвобождающиеся наружу при их гибели обладают сверхвысоким коэффициентом светопоглощения – около 10 в 6 степени. Их яркое флуоресцентное свечение и регистрирует лаборант в том случае, если в исследуемом образце кала имеется скрытая кровь. Однако в России этот метод диагностики не очень популярен, особенно в сравнении с бензидиновой пробой.
Плюсы:
-
Оперативность;
-
Доступная цена;
-
Относительно высокая точность – около 80%.
Минусы:
-
Необходимость в соблюдении диеты, поскольку порфирины присутствуют в любом гемоглобине, в том числе и в животном.
Расшифровка результатов анализа на скрытую кровь
В зависимости от того, каким способом проводился тест, и каков внутренний регламент лаборатории, ответ вы получите через 1-6 дней. Из описания методов проведения этого исследования видно, что его результаты не могут быть выражены в точном цифровом эквиваленте: в бензидиновой и гваяковой пробе реагент либо окрашивается, либо нет – разнится только скорость и интенсивность окраски. Что касается иммуноферментного и флуоресцентного теста, то тут тоже все однозначно: вторая полоска либо проявляется, либо нет, также и свечение – либо есть, либо нет.
Для примера рассмотрим расшифровку результатов анализа кала на скрытую кровь по методу Грегерсена (бензидиновая проба):
|
Значение |
Интерпретация |
|
— |
реакция отсутствует |
|
+ |
слабо выраженная реакция |
|
++ |
средне выраженная реакция |
|
+++ |
ярко выраженная реакция |
|
++++ |
очень интенсивная реакция |
Ложные результаты
Рассмотрим теперь, по какой причине итоги исследования могут оказаться необъективными:
-
Ложноотрицательный результат анализа кала на скрытую кровь – это почти всегда следствие нарушения технологии проведения пробы или недоброкачественности реактивов. Может быть и так, что пациент предоставил мало биоматериала или поленился собрать его из разных фрагментов каловых масс. Кроме того, при некоторых заболеваниях органов ЖКТ, например, при полипозе толстого кишечника, новообразования кровоточат не постоянно, а эпизодически. Поэтому исследование рекомендуется повторять несколько раз, особенно если есть серьезные основания подозревать болезнь;
-
Ложноположительный результат анализа на скрытую кровь – это, в большинстве случаев, следствие пренебрежения правилами подготовки. Либо пациент не соблюдал предписанную врачом диету, либо принимал какие-либо медикаменты, исказившие картину исследования, либо допустил травмирование, приведшее к попаданию крови в желудочно-кишечный тракт. У грудных детей положительный результат анализа кала на скрытую кровь может оказаться ложным, если соски кормящей матери потрескались и кровоточат – тогда малыш заглатывает кровь в процессе кормления, и она оказывается в его испражнениях. Причем, эту проблему не удастся решить методом сцеживания, кровь и в этом случае может попасть в грудное молоко. Лучше на три дня перевести младенца на искусственную смесь, чтобы иметь уверенность в объективности теста.
Положительный результат – что делать?
Встревоженных пациентов, в первую очередь, волнует вопрос: что означает положительный результат анализа кала на скрытую кровь? Во-первых, это точно не повод для паники. Мы уже обсудили довольно высокую вероятность ошибок, особенно при нарушении правил предварительной подготовки. Нужно обязательно повторить исследование не менее трех раз, прежде чем делать окончательные выводы.
Во-вторых, даже если положительный результат оказался достоверным, он, скорее всего, сигнализирует о наиболее распространенных диагнозах:
-
Геморрой, трещина заднего прохода;
-
Полипоз, поликистоз или дивертикулез кишечника;
-
Неспецифический язвенный колит;
-
Язва желудка или двенадцатиперстной кишки;
-
Паразитарная инвазия;
-
Варикозное расширение вен пищевода.
Безусловно, все эти заболевания крайне неприятны и потенциально опасны, но основное беспокойство у людей, получивших на руки положительный результат исследования кала на скрытую кровь, вызывает риск развития рака. Чтобы полностью разобраться в ситуации, необходимо подключить дополнительные методы диагностики: УЗИ органов брюшной полости, рентгеноконтрастную томографию, колоноскопию, ректороманоскопию.
Особенно важно это сделать тем пациентам, чей возраст перевалил за 40 лет, и у кого при этом есть близкие родственники, болевшие раком. Что касается злокачественных опухолей кишечника, то ранняя диагностика повышает шанс на выживание в среднем на 30%. А иммунохимический анализ, например, показывает первую стадию колоректального рака более чем в 90% случаев, аденоматозные полипы размером свыше 1 см – в 60% случаев. Вот почему так важно не пренебрегать ежегодными профилактическими обследованиями и прислушиваться к рекомендациям лечащего врача. Берегите себя, и будьте здоровы!
www.ayzdorov.ru
Суть анализа
Анализ кала на скрытую кровь показывает наличие кровяных частиц, которые нельзя увидеть под микроскопом при проведении копрограммы. Подобное исследование входит в число распространённых и позволяет вовремя обнаружить кровотечение из органов желудочно-кишечного тракта.
Нарушения целостности слизистой могут возникать в верхнем или нижнем отделе пищеварительной системы. В первом случае частички крови подвергаются биохимическим процессам и, попадая в каловые массы, приобретают бордовый или коричневый цвет. Если повреждение тканей произошло в области толстого кишечника, обнаруженные выделения остаются алыми.
При тяжёлых заболеваниях, например, злокачественных, скрытая кровь бывает единственным симптомом начальной стадии. Своевременная диагностика даёт возможность начать правильное лечение и сохранить здоровье пациента.
Когда назначают обследование
Анализ проводят при подозрении на заболевания, угрожающие жизни, или для выявления причины патологических состояний, связанных с нарушением обмена веществ. Показания к исследованию кала на кровь, следующие:
- Гельминтоз.
- Постоянная рвота, изжога или тошнота.
- Язва желудка.
- Абдоминальные боли неясного происхождения.
- Жидкий стул.
- Чрезмерная потеря массы тела.
- Диагностика состояния слизистых органов ЖКТ.
- Нарушения пищеварительной функции.
Кроме всех этих ситуаций, врачи назначают исследование кала на своё усмотрение. Пациенту лучше согласиться с доктором и провести дополнительный анализ, так как он поможет поставить максимально точный диагноз. Таким образом, реакция на скрытую кровь необходима для получения информации о наличии повреждений стенок пищеварительных органов.
Виды анализов на скрытую кровь
Современные методы исследования более точны и показательны, чем те, что использовались ещё несколько лет назад. Выявить скрытую кровь помогают два метода.
Бензидиновая проба
Была долго популярна, так как позволяла определить даже низкие концентрации кровяных составляющих. Принцип действия основан на выявлении гемоглобина – основного компонента эритроцитов. Для этого используют химическую реакцию в результате которой железо в составе гема окисляется перекисью водорода и приобретает синий цвет.
Недостаток метода – его не специфичность. То есть положительная реакция получается при воздействии на атом железа любого происхождения, даже животного и растительного. Из-за этого пациенту необходимо проходить специальную подготовку, где важно соблюдать определённую диету.
Иммунохимический анализ
Является более точным исследованием. Назначается как самостоятельно, так и в дополнение к другим методам для уточнения их результатов. Принцип действия отличается от предыдущего. Здесь в основе лежит определение концентрации специфических антител, которые вырабатываются у человека в ответ на попадание антигенов. Метод чаще используется при патологиях инфекционного генеза. Из недостатков отмечается длительность выполнения – окончательные результаты и диагноз становятся известны только через 1–2 недели.
Никакой вид анализа не предполагает внутренних вмешательств или дополнительных повреждений. Высокая чувствительность реактивов требует некоторой подготовки пациента, чтобы результаты оказались достоверными.
Подготовка к анализу
Соблюдение нижеперечисленных рекомендаций врача поможет получить более точные данные и минимизировать погрешность.
- Лекарственные препараты, которые способны повлиять на результаты, отменяют за 1 неделю до проводимого анализа.
- За сутки до исследования нужно исключить возможные повреждения ротовой полости, в том числе при чистке жёсткой зубной щёткой или употреблении твёрдой пищи.
- Женщины должны сдавать анализ в период отсутствия менструаций.
- За несколько дней до взятия биоматериала нужно соблюдать диету. Нельзя есть продукты, содержащие железо (мясо, рыба, помидор, свёкла). При иммунохимическом методе ограничения могут не соблюдаться.
- Предварительно не разрешается проводить искусственное опорожнение клизмами и слабительными средствами (даже на основе растительных компонентов).
Как правильно собрать кал?
Правила забора биоматериала также важны, как подготовка к анализу. Исследуемый образец должен быть свежим, поэтому испражнения доставляют в лабораторию как можно быстрей.
Чтобы правильно сдать анализ, нужно руководствоваться следующими рекомендациями:
- Подготовить ёмкость для сбора биоматериала. Лучше использовать специальные баночки, которые продаются в аптеках и уже содержат лопатки для забора образца.
- После дефекации собрать сухой остаток испражнений без воды и мочи, которая случайно может на них попасть. Лучше это делать утром, чтобы биоматериал сразу отнести в лабораторию.
- Количество, необходимое для исследования, составляет 3 фрагмента каловых масс, которые берутся из разных участков. Для этого используется чайная ложка или шпатель из аптечной ёмкости.
- Биоматериал нужно доставить в лабораторию не позже, чем через 3 часа. До этого момента и во время транспортировки рекомендуется хранить образец материала в холодильнике.
Расшифровка анализов
Результаты анализов сравниваются с показателями, которые считаются нормой. Врачи допускают попадание в кишечник до 2 мл крови ежедневно. Если обнаруженных частиц больше этого количества, результат считается положительным и доктор имеет основания подозревать внутреннее кровотечение. Когда скрытая кровь не выявлена или её концентрация меньше 1 мг на 1 г кала, результаты исследования считаются отрицательными. Врачи принимают во внимание только повышенные значения.
Из-за неправильной подготовки к исследованию, полученный результат всегда оказывается ошибочным. Врачи отмечают, что искажения данных возникают как в сторону положительных результатов, так и отрицательных. Чтобы не сомневаться в полученных показателях, исследование рекомендуется повторить даже без наличия на то оснований.
Известно, что при некоторых заболеваниях патологическая кровоточивость наблюдается не постоянно, а периодически, а это затрудняет её выявление. Если предварительный диагноз известен, например, полипы кишечника, то отсутствие гемоглобина вызовет сомнения и потребуется повторный анализ. Именно поэтому для диагностики пациента врачи назначают несколько видов обследований – лабораторные, инструментальные.
О чем говорит положительный результат
Повышенное количество гемоглобина в кале часто подтверждает повреждения органов ЖКТ и наличие патологий. Положительный анализ даёт основания предположить одно из следующих состояний:
- Болезнь Крона.
- Кровотечение, вызванное варикозным расширением вен пищевода.
- Злокачественное образование или полипы.
- Неспецифический язвенный колит.
- Трещина заднего прохода, механические повреждения из-за запора или геморрой.
- Проблемы ротовой полости.
- Заражение гельминтами.
- Язвенное поражение желудка или 12-перстной кишки.
Так как положительный результат предполагает серьёзные патологии, пациенту следует убедиться в достоверности полученных данных и повторить анализ. Небольшие погрешности в питании или случайные повреждения ротовой полости приводят к ложным показателям, а поэтому важно правильно подготовиться к первому обследованию.
Способ повторного исследования выбирается врачом – это может быть второй лабораторный анализ или изучение кишечника с помощью эндоскопа. Часто при получении подтверждения присутствия скрытой крови, особенно иммунохимическим методом, пациенту рекомендуют сделать также колоноскопию.
Дополнительное изучение кишечника поможет подтвердить или опровергнуть наличие кровоточащих полипов или других новообразований. Целесообразность алгоритма двойного обследования доказана в скрининговых программах. Благодаря такому подходу смертность пациентов удалось снизить на 25%.
Расшифровка результатов проводится только врачом, который учитывает допустимые нормы, анамнез пациента, клиническую картину, показатели других обследований. Самостоятельно интерпретировать полученные данные или пытаться их скорректировать лекарственными препаратами нельзя.
Заключение врача
Только комплексная диагностика даст возможность установить точную причину патологии и принять решение о необходимой терапии. Подробное исследование кала, в том числе на скрытую кровь, рекомендуется проводить ежегодно в профилактических целях. При этом его нужно делать 2–3 раза или совмещать с другими методиками.
projivot.ru